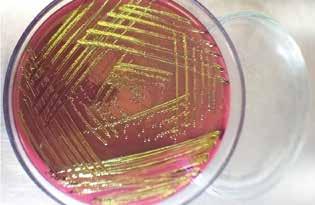

EL CRIMEN DE HERNÁN HENAO, 20 AÑOS DE IMPUNIDAD
P. 6
CON TESIS DE GRADO LOGRARON REVISIÓN DE SOBRETASA A LA GASOLINA
P. 11
LA INVASIÓN DEL PLÁSTICO
P. 18
SOSTENIBILIDAD DE LAS IES, BASE PARA MODIFICAR LA LEY 30
P. 22

Maestras de la velocidad y el vuelo
Colombia tiene cerca de 500 de las 6000 especies de libélulas identificadas en el mundo. Estos maravillosos insectos, con sus colores vistosos y su vuelo ágil, son especialistas en ríos, pantanos, cascadas y plantas. La Universidad de Antioquia ha sido pionera en su estudio y en la actualidad custodia 6368 ejemplares.
686 MAYO MEDELLÍN 2019 DIRECCIÓN DE COMUNICACIONES ALMAMATER@UDEA.EDU.CO @UNIVERSIDADDEANTIOQUIA @UDEA VIGILADA MINEDUCACIÓN ISSN 1657-4303
N.º
¿Por qué cuesta tanto encontrar trabajo? ¿Tengo lo que buscan las compañías? ¿Dónde tengo más probabilidades de emplearme? Académicos y empresarios dan pistas para el caso colombiano.
#DESARROLLOPROFESIONAL
STIVEN ARIAS HENAO Periodista stiven.arias@udea.edu.co
Tendencias y habilidades para emplearse en Colombia
«¿Qué más mijo?, ¿mucho camello?». Ese popular saludo antioqueño —que equipara «camello» con «trabajo»— devela la común preocupación por conseguir empleo y mantenerlo. De hecho, la escena del cesante buscando trabajo en las páginas del periódico o en internet no pasa de moda. Según los expertos, para que la búsqueda sea exitosa hoy, más que nunca, es importante reinventar las habilidades laborales propias. Y el panorama del mercado laboral colombiano lo ratifica.
Mauricio López González, coordinador del Grupo de investigación en Macroeconomía Aplicada de la Facultad de Ciencias Económicas de la Universidad de Antioquia, señaló que cerca de 22 millones de colombianos laboran actualmente, es decir, aproximadamente el 48 % de la población. En enero de 2019, el índice de desempleo alcanzó cifras particularmente altas en comparación con los meses previos: 12.8 %. Incluso es la más alta desde el año 2013.
Casi la mitad de los colombianos que laboran —dijo el investigador— en realidad tienen empleos informales, es decir que no tienen acceso a seguridad social, ni salud ni pensión. Entre noviembre de 2018 y enero de 2019, la informalidad laboral en el país alcanzó el 46.4 %.
Los jóvenes y las mujeres siguen siendo las poblaciones más vulnerables. Mientras que el 8 % de los hombres colombianos están desempleados, la cifra en mujeres es del 14 %, y en jóvenes es del 18 %. Por esa razón, López recalcó que «estos son grupos en los que la política pública debe fijar la atención».
El economista también identificó que una de las razones de la problemática es el bajo aporte de la industria colombiana, pues esta solo concentra el 15 % de los empleos del país. En contraste, el aporte de la industria a la generación de empleo en un país económicamente más desarrollado como Corea del Sur alcanza el 25 %. Mientras que la tasa de desempleo en 2018 en Colombia fue del 10 %, en el país asiático alcanzó solo el 3.7 %.
Antioquia disímil
Un estudio que el Grupo de Macroeconomía Aplicada realizó, en colaboración, y con el financiamiento de Comfama, evidenció las profundas disparidades laborales de tres subregiones antioqueñas: Urabá, Oriente y Suroeste. «Oriente tiene un dinamismo económico muy importante —indicó López—. Allí la tasa de desempleo
en jóvenes en 2018 fue del 9.2 %; en el Suroeste fue de 17.5 %, y en Urabá del 20.4 %». Similar es el caso con otros indicadores, como la informalidad y el subempleo.
Los investigadores calcularon la probabilidad de obtener un empleo formal en las tres subregiones. Los resultados fueron: 75 % para Oriente, 63 % para Urabá y 45 % para el Suroeste. Los desajustes entre la oferta y la demanda de mano de obra son una de las claves. «Los empleadores dicen que están necesitando ciertas cualidades en los empleados, pero los oferentes tienen otras características. Parece que algunos programas educativos no logran satisfacer las demandas de las empresas», sugirió el investigador.
Otro factor que dificulta el hallazgo de vacantes laborales es que los empresarios demandan habilidades que los postulantes no siempre poseen. La carencia de las denominadas «competencias blandas», como el liderazgo y el trabajo en equipo, inclinan la balanza en contra del aspirante, aunque tenga capacidades técnicas sobresalientes.
Tasa de desempleo en jóvenes durante 2018

Carlos Mario Guisao Bustamante Director de Comunicaciones Luz Adriana Ruiz Marín Jefa División de Contenidos Medios y Eventos
Luis Javier Londoño Balbín Coordinador de medios impresos
Pedro León Correa Ochoa Coordinación de edición
John Sebastián Otálvaro Pérez Corrección de texto
Víctor Aristizábal Giraldo Diseño y diagramación
2 N.º 686 · mayo de 2019 · Universidad de Antioquia
Portada Fotografía: cortesía Cornelio Bota Sierra. Libélula de la especie Mesamphiagrion rosseri.
Comité editorial: Elmer Gaviria Rivera · Vicerrector General Clemencia Uribe Restrepo Secretaria General Patricia Nieto Nieto Profesora de la Facultad de Comunicaciones Fabio Humberto Giraldo Jiménez · Profesor del Instituto de Estudios Políticos Álvaro Sanín Posada · Profesor de la Facultad de Medicina ALMAMATER@UDEA.EDU.CO @UNIVERSIDADDEANTIOQUIA @UDEA DIRECCIÓN DE COMUNICACIONES Ciudad Universitaria · Calle 67 N.º 53-108, bloque 16, oficina 336, Medellín · Teléfono: (4) 2195026 N.º 686 MAYO MEDELLÍN 2019 Las opiniones expresadas en ALMA MATER son responsabilidad de los autores y solo a ellos compete. ISSN 1657-4303
El lente de las empresas
Pero no solo la academia tiene su lupa sobre los desajustes entre la oferta y la demanda de mano de obra. La empresa privada también. Así lo ratificó Francisco Javier Echeverry Hincapié, gerente nacional de Manpower Group, empresa con presencia en 80 países que suma siete décadas gestionando oportunidades laborales. Echeverry es contador público egresado de la Universidad de Antioquia y magíster en Administración por la Universidad Eafit.
«En el mundo, las personas estudian, en buena medida, lo que las empresas del sector privado no necesitan», sentenció Echeverry. Al respecto, Manpower Group encuestó a más de 39 mil empleadores de todo el mundo, incluyendo de Colombia. El 45 % de los participantes afirmaron tener serios problemas para encontrar el talento humano que necesitan. En Colombia, el 42 % de los empleadores opinaron igual.
En enero de 2019, el índice de desempleo en Colombia fue de 12.8 %, la cifra más alta desde el año 2013
Existen otras razones para la baja empleabilidad de los jóvenes en las compañías. Por ejemplo, estas últimas no siempre ven en las prácticas laborales de sus aspirantes una experiencia significativa. De otro lado, aunque las habilidades técnicas siempre son importantes, las empresas cada vez privilegian más las habilidades humanas y la inteligencia emocional.
Otras habilidades apetecidas, según Echeverry, son el pensamiento analítico, la capacidad de resolver problemas complejos, y la capacidad y la voluntad de aprendizaje. «Por eso requerimos ciclos más cortos de desarrollo de habilidades. No quiere decir que las profesiones y carreras no sean importantes, sino que debemos reinventar las habilidades profesionales con ciclos formativos cortos», dijo. Según Echeverry, empleadores de todo el mundo están perfilando algunas profesiones y habilidades que requerirán en mayor medida, y otras cuya demanda decrecerá. Entre las primeras están: comunicación y construcción de relaciones, carreras relacionadas con tecnologías de la información y la comunicación TIC , y seguridad informática. Entre las segundas figuran: mantenimiento de registros, seguimiento de costos, y finanzas y contabilidad.
En ese sentido, de acuerdo con el egresado de la Alma Máter, uno de los perfiles profesionales que más dinero devenga hoy en Estados Unidos se denomina «científico de datos». Se trata de personas que analizan grandes cantidades de datos con técnicas de big data, y generan valor para las compañías. «En Colombia es muy difícil conseguir uno; solo hay cerca de 50», dijo.
A pesar de la paranoia colectiva que a menudo genera el boom tecnológico e informático de la denominada cuarta revolución industrial, el gerente nacional de Manpower Group enfatizó en que «las empresas que más invierten en automatización y digitalización son las que más empleos están generando. Nos estamos distrayendo pensando que las máquinas nos van a dejar sin empleo cuando la cuestión realmente es cómo vamos a desarrollar las habilidades necesarias para insertarnos». Por supuesto, la evolución del mercado global también supone retos para las empresas. Para Echeverry, uno de ellos es entender que, en algunas profesiones ampliamente
demandadas, son los trabajadores quienes deciden cuándo, cómo y dónde trabajar. Los empleadores deben entender que los nuevos talentos buscan flexibilidad horaria, confort y obtener los conocimientos necesarios para laborar en lo que disfrutan. Así las cosas, «camellar» es un verbo que deben conjugar tanto postulantes como empresarios.

Para profesionales de la Universidad de Antioquia
El Programa de Egresados de la Universidad de Antioquia lidera el Centro de tutorías y asesorías laborales y sicológicas, un espacio de conversación en el que esta población puede consultar, con profesionales del derecho y la sicología, sus inquietudes acerca de derecho laboral, prestaciones sociales, presentación de la hoja de vida, enfoque vocacional, entre otras necesidades y habilidades para el mundo del trabajo.
Además, el Programa realizará una Feria Laboral Virtual entre el 20 y el 26 de mayo en la cual las organizaciones podrán ofrecer sus vacantes con perfiles específicos de todas las áreas del conocimiento de la Universidad; los graduados podrán actualizar la hoja de vida y aplicar a las ofertas de empleo de su mayor interés. Será un espacio virtual de encuentro e interacción para el acceso de los #EgresadosUdeA a más de 8000 organizaciones que buscan profesionales de la mayor calidad.
3 N.º 686 · mayo de 2019 Universidad de Antioquia
Foto: Fancycrave / Unsplash Photo Community.
En Londres, Juan Camilo Chacón, biólogo egresado de la Alma Máter, reconstruye la historia de poblaciones latinoamericanas y de especies animales en peligro de extinción.
#ORGULLOUDEA
El genetista, el historiador, el guardián
Un descomunal calamar gigante, los huesos de una colosal ballena azul y el imponente esqueleto de un tiranosaurio rex. Todo en el Museo de Historia Natural de Londres, hasta la arquitectura de su rincón más inadvertido, fue diseñado para impresionar. Sus visitantes lo saben; pero muchos desconocen que ese predio de botánicos, entomólogos y paleontólogos reconocidos es, también, dominio de un genetista colombiano con vocación de historiador y alma de salvaguarda de la vida.
Su nombre es Juan Camilo. Su sencillez y jovialidad se reflejan más en la amigable mención de su nombre que en la formal alusión a Juan Camilo Chacón Duque, el doctor en Genética Evolutiva Humana por el University College de Londres. Él, persona antes que experto, aprendió a ser cálido y amable en Marinilla, Antioquia, donde nació en 1988.
La labor que adelanta como investigador del Museo de Historia Natural está en la frontera de varias ciencias, como dejan ver las denominaciones de sus áreas de estudio: genética evolutiva, ADN antiguo y genómica. Para llegar allí hizo gala de los saberes y las pericias con que lo equipó la Universidad de Antioquia cuando egresó del pregrado en Biología, en el 2009, y de la maestría en la misma área, en 2013.
Con espíritu apasionado e inquisitivo, Juan Camilo busca muestras biológicas —piel, huesos o cualquier fuente de ADN— custodiadas en diferentes museos del mundo para estudiar las variaciones genéticas que han sufrido en los últimos dos siglos algunas especies animales del hábitat colombiano —la investigación hace parte del proyecto GROW Colombia—. Un ejemplo es el oso de anteojos, al cual el ser humano le clavó en sus lomos la siniestra leyenda de «especie en peligro de extinción», escrita con tinta de sangre y ceniza.
«La diversidad genética —explicó— se refiere a los cambios que se introducen por mecanismos naturales en la genética de los organismos. Entre más diversos sean, más posibilidades tendrán de adaptarse a un cambio medioambiental».
Su convicción revela el guardián de la naturaleza que lleva dentro. La suya es una carrera contra el tiempo para descubrir atajos que permitan salir al corte de la erradicación de especies que avanza con cada sutil vibración de los relojes.
De sus exploraciones obtuvo la más emocionante de sus convicciones: disfruta como nada investigar la historia con la genética como herramienta. Podría decirse que es un detective tras el rastro de la historia de especies animales y de poblaciones humanas. ¿Quién lo creyera? ¡La genética como lupa que desnuda las huellas que sepultó el pasado!
En su tesis de doctorado estudió la historia genética de más de 6000 personas de cinco países latinoamericanos: Colombia, Perú, Chile, México y Brasil. El estudio tuvo lugar en el marco del Consorcio para el análisis de la diversidad y la evolución de Latinoamérica —Candela—. «Encontramos señales de historias pasadas que no fueron tan bien documentadas por su naturaleza clandestina», dijo. Detrás de esa advertencia hay una especie de grito de investigador, una especie de «¡goool!». Se refiere a la migración que hicieron hasta el Nuevo Mundo, judíos conversos al cristianismo y también practicantes del judaísmo. Un grupo representativo de estos fueron expulsados de España durante la época de la Colonia. La investigación arrojó que el 23 % de los latinoamericanos participantes del estudio tiene algún porcentaje de ancestría sefardí, es decir, judeoespañola.

Pero el potencial de este tipo de estudios va más allá de reconstruir el pasado de las poblaciones, lo que es en sí mismo un mérito fuera del alcance de muchos registros históricos. Otros de sus frutos podrían estar relacionados con tratar de entender por qué la nariz en personas de una población es más grande, por qué las facciones del rostro en ciertas comunidades son tan singulares, o por qué algunas poblaciones son más propensas a determinadas enfermedades.
Juan Camilo se ha convertido en un referente de la genética evolutiva y un pionero en el uso conjunto del ADN antiguo y la genómica en Colombia.
Gabriel de Jesús Bedoya Berrío, uno de sus mentores en la Alma Máter, le atribuye su éxito a la facilidad con que comprende conceptos complejos de ciencias biológicas y a su persistencia. Virtudes como esas son otras de las brillantes condiciones de Juan Camilo, el científico antioqueño que se mueve a través de la corriente del tiempo en el «vehículo» de la genética.
4 N.º 686 · mayo de 2019 · Universidad de Antioquia
STIVEN ARIAS HENAO Periodista stiven.arias@udea.edu.co
Juan Camilo Chacón trabaja actualmente en el Museo de Historia Natural de Londres. Foto: cortesía Juan Camilo Chacón.
La obtención de péptidos antibióticos que atacan bacterias —un desarrollo en el que participó la profesora de la Universidad de Antioquia, Ligia Corrales García—, derivó en una patente con licencia para explotación comercial en México.
#UDEACIENCIA
Antibióticos troyanos
¡Las bacterias y virus están en todas partes! En las monedas con las que pagamos el bus, en las cerraduras de las puertas, en un apretón de manos… Son batallones de invisibles soldados que acechan a los seres humanos a cada segundo. Pese a ello, en términos generales, nos mantenemos sanos y como todo organismo vivo sabemos cómo escudarnos.
La piel, por ejemplo, produce las defensinas humanas, una familia de proteínas que son péptidos antibióticos y que protegen el cuerpo. Están en las mucosas orales y nasales, y también en órganos como el pulmón, las glándulas salivarias, el intestino, el estómago, los riñones y los ojos.
Simulando ese modelo de protección natural de nuestro cuerpo, los científicos han recurrido al genoma humano para encontrar las secuencias primarias de esa familia de proteínas y usarlas como una especie de «caballo de Troya» —aquella gigantesca estructura de madera mencionada por Homero en la Odisea y que llevaba en su interior, escondidos, a un grupo de guerreros como una estrategia para introducirse en la ciudad fortificada de Troya y, así, tomar el control de ella—. Como en el relato de Homero, un grupo de científicos —entre ellos Ligia Luz Corrales García— pusieron a prueba su astucia y se dieron a la tarea de desarrollar un nuevo péptido para el control de infecciones causadas por bacterias resistentes a distintos antibióticos comerciales.
«Se denomina péptido recombinante por la manera en que es obtenido este antibiótico —explicó Corrales García, profesora de la Facultad de Ciencias Farmacéuticas y Alimentarias—. Es tomar una secuencia genética, en este caso de las defensinas, ponerla dentro de un plásmido y este a su vez dentro de una bacteria». Parte del juego es que la bacteria puede aceptar o rechazar ese tipo de «caballo de Troya» que sería el plásmido.
Defensinas: familia de proteínas que protege el cuerpo gracias a sus propiedades antibióticas.
Como parte del doctorado en Ciencias Bioquímicas de la Universidad Autónoma de México, Ligia Corrales y el equipo dirigido por el profesor mexicano Gerardo Corzo Burguete, probaron esta estrategia contra cepas de bacterias como Escherichia coli, Staphylococcus y Salmonella. Después de comprobar que funcionaba, el equipo decidió probarla en un paciente aislado en un hospital mexicano, contra una cepa de Mycobacterium tuberculosis, resistente a múltiples drogas.
«Resultó que esta defensina era capaz de inhibir el crecimiento de esa bacteria que da origen a la tuberculosis», añadió la ingeniera de alimentos.
Estos péptidos también pueden ser obtenidos de manera distinta a la biológica, a través de un proceso denominado síntesis química, pero es más costoso y genera muchos más desechos contaminantes que el recombinante.
Según Gerardo Corzo, doctor en Ciencia de los Alimentos, se estima que para el año 2050 alrededor de 10 millones de personas serán afligidos por infecciones de bacterias multirresistentes a los antibióticos, «siendo más susceptibles los individuos con un sistema inmunológico comprometido».
Corzo indicó que la defensina es una molécula clave en la inmunidad innata de los humanos, actúa como barrera frente a las invasiones
por bacterias patógenas, «y por tanto es una posible alternativa a esta problemática».
El desarrollo de péptidos antibióticos puede tener una aplicación terapéutica, por ejemplo, en medicamentos de uso tópico, de forma oral o con inyecciones, contra estas infecciones. La investigación derivó en una patente por la cual una empresa mexicana está evaluando la manera de llevar el péptido antibiótico a la producción final.
Según la profesora Corrales, su perspectiva de trabajo está en la producción de proteínas recombinantes contra enfermedades huérfanas, aquellas que son crónicas debilitantes, poco frecuentes y afectan a pocas personas, pero cuyos medicamentos son costosos por la lógica económica de la baja demanda y la búsqueda de utilidades. En esta línea de investigación, las bacterias modificadas genéticamente para que produzcan antibióticos pueden servir como una estrategia ingeniosa, como el simbólico caballo.

5 N.º 686 · mayo de 2019 Universidad de Antioquia
JUAN DIEGO RESTREPO TORO Periodista juan.restrepo16@udea.edu.co
Ilustración: Felipe Uribe Morales.
El profesor Hernán Henao Delgado fue asesinado en su oficina, en el Campus de la Universidad de Antioquia, el 4 de mayo de 1999. Ante su crimen, aún impune y a punto de prescribir, su familia pide la declaratoria de lesa humanidad.
#HACEMOSMEMORIA
NATALIA MARÍA MAYA LLANO Periodista natalia.maya@udea.edu.co
El crimen de Hernán Henao, 20 años de impunidad

«Si lo hubieran escuchado hablar cinco minutos, no lo habrían matado», repite, una y otra vez, Dora Tamayo, la profesora universitaria con la que Hernán Henao Delgado se casó, tuvo dos hijas y compartió su vida hasta el día de su asesinato. Quienes lo conocieron coinciden en una pregunta: «¿Por qué lo asesinaron?».
De su natal Manizales viajó a Bogotá para estudiar antropología en la Universidad Nacional, donde la maestra Virginia Gutiérrez de Pineda le inspiró el interés por estudiar la familia en Colombia. Luego, en 1970, Henao llegó a la Universidad de Antioquia. Tras esa primera experiencia viajó a Estados Unidos para cursar una maestría en Antropología, en la Universidad de Berkeley. Su regreso marcó el inicio de una trayectoria promisoria en la Alma Máter: fue decano encargado de la recién creada Facultad de Ciencias Sociales, jefe del Departamento de Antropología y delegado ante el Comité Regional para la Promoción de la Familia.
En 1993 asumió el cargo de director del Instituto de Estudios Regionales —Iner— hasta el 4 de mayo de 1999, día en el que dos hombres y una mujer —con capuchas y armas con silenciador— ingresaron a su oficina en el bloque 9 de la Ciudad Universitaria y le dispararon.
Desde 1991, «el hombre del optimismo y la franca sonrisa» —como lo describen sus amigos—, había insistido en que a la universidad y a las ciencias sociales y humanas les correspondía hacer escuchar su voz en medio de metrallas y sangre derramada: «Hasta que se entienda que su palabra no es de guerra ni amenaza el bien público».
Según recuerda Sandra Turbay, estudiante y posteriormente colega de Henao, su voz siempre se hizo escuchar, incluso cuando en medio de la violencia sin tregua que padeció Medellín en los años noventa, fue llamado a integrar la Consejería Presidencial, que tenía como propósito formular políticas y acciones para superar la inseguridad y violencia que vivía la ciudad.
Pero su voz, según investigadores y fiscales* adscritos al Despacho 15 de la Fiscalía de Justicia Transicional —antes Justicia y Paz—, también fue escuchada por los grupos paramilitares: «En el libro Mi Confesión, Carlos Castaño acusa al doctor Henao de hacerle un doble juego a la guerrilla con la publicación, en 1998, Desarraigo y futuro: vida cotidiana de familias desplazadas de Urabá. Creemos que esa investigación les generó mucha incomodidad a terratenientes y al sector paramilitar de Urabá, desencadenando la ira de Castaño y de su gente».
6 N.º 686 · mayo de 2019 · Universidad de Antioquia
Foto: Hernán Henao Delgado. Foto: cortesía Instituto de Estudios Regionales —Iner—.
Con esta información, un video y una carta pública del 29 de noviembre de 2000, donde integrantes anónimos de la banda La Terraza se atribuían los asesinatos de Jaime Garzón, Elsa Alvarado, Mario Calderón, Jesús María Valle, Eduardo Umaña y Hernán Henao, en 2017 los investigadores y fiscales le solicitaron a Dora Tamayo el reporte del asesinato de su esposo, que hasta entonces solo tenía proceso abierto en la justicia ordinaria —Fiscalía Nacional Especializada de Derechos Humanos—. Los investigadores y fiscales de Justicia Transicional encontraron numerosas coincidencias en los casos de Eduardo Umaña y Hernán Henao, que comportaron un mismo modus operandi a los de Jesús María Valle y los investigadores del Cinep, crímenes previamente aceptados por Diego Fernando Murillo Bejarano, alias Don Berna, quien atendiendo las órdenes de Carlos Castaño contrató los servicios sicariales de La Terraza.
«El perfil de todas estas víctimas, los dos hombres y la mujer que los abordaron en sus oficinas, el tipo de arma, las heridas causadas en el parietal a la altura de la oreja, nos llevan a concluir que no se trató de homicidios aislados, se trató efectivamente de un ataque sistemático en contra de defensores de derechos humanos, catedráticos y todo aquel que pusiera en evidencia las actividades paramilitares y de algún modo el vínculo que estos tenían con algunos miembros de la Fuerza Pública», recalcó el investigador.
En septiembre de 2018 se le realizó una audiencia de imputación de cargos a Don Berna por los asesinatos de Umaña y Henao. El exparamilitar no asistió, pero envió a su abogada. De acuerdo con un fiscal del Despacho 15, «los hechos completos se presentarán en las sesiones de las audiencias de formulación de cargos, cuyas fechas deberán ser programadas por la Sala de Conocimiento de Justicia y Paz, ahora Justicia Transicional, a partir de la petición que ya se radicó».
«Habrá justicia y verdad cuando se conozca quién o quiénes fueron los determinadores de esa acción contra el profesor e investigador», insistió el abogado apoderado del caso, Alberto León Gómez. Por esta razón, antes del 4 de mayo —fecha en la que prescribiría la acción penal—, Gómez radicó una petición para que el crimen sea declarado de lesa humanidad, lo hizo ante el Tribunal Superior de Medellín Sala de Justicia Transicional y ante la Fiscalía Nacional Especializada de Derechos Humanos; y, posteriormente, solicitará una medida ante la Comisión Interamericana de Derechos Humanos —CIDH— por la denegación de justicia que ha habido en el caso.
La prescripción del crimen de Henao, según Vladimir Montoya Arango, director del Iner, representaría una enorme frustración y una vergüenza histórica. «Sin el maestro, sin el intelectual comprometido que era —advirtió Montoya—, tenemos un vacío permanente, pero también mantenemos el faro luminoso de su legado y de sus enseñanzas, por eso no permitiremos que la idea de prescripción de este crimen atroz pretenda imponernos la clausura de la verdad y de la memoria, tan necesarias para la reconciliación, la reparación y la insistencia en la no repetición».
Lo que más esperan Dora Tamayo y sus hijas, en palabras de la primera, es que por fin se sepa la verdad: «Quiénes y por qué mandaron a matar a Hernán».
*No se mencionan los nombres por petición de las fuentes.
El humanista
Hernán era una persona de avanzada, un tipo muy culto y brillante, de una cultura no solamente en el área de la antropología, sino también en filosofía, en literatura, en historia. La gran característica de Hernán era que fue una persona absolutamente bondadosa, era un tipo del cual uno se enamoraba de su personalidad y de su queridura.
Luis Fernando García, amigo.
Cuando conmemoramos los 10 años de su deplorable asesinato, alguien muy cercano a él dijo que Hernán nos había hecho creer una mentira: que todos éramos sus mejores amigos, y sí, nos convenció de ello y nos hacía sentir como sus mejores amigos.
Olga Lucía López, colega.
El profesor universitario
Hernán era un convencido de la educación, principalmente de la educación pública. Fue un maestro, eso no se lo pueden quitar; un profesor universitario a carta cabal, comprometido con la Universidad de sol a sol, y más. También, por su conocimiento de este país, que tanto había recorrido, al estar seguro de que había que conocerlo, describirlo y proponer, terminó su vida enfocado en los estudios regionales, aunque sin desprenderse del tema de la familia, por el que tanto indagó. Fueron sus principales intereses: familia, región, localidades, tradición, instituciones, cultura.
Dora Tamayo, esposa.
Muchos lo recordamos por la risa. Tenía una carcajada sonora, fresca, alegre, que revelaba lo que había en su interior: una persona bondadosa. Fue un magnífico profesor: responsable, comprometido; quería que sus alumnos aprendiéramos y nos daba todo lo que él sabía, que era mucho porque estaba muy actualizado. Así en esa época no tuviéramos internet, él nos transmitía todo lo que había aprendido. También hay que destacar todas sus experiencias creando vínculos entre la academia y el sector externo, lo que logró desde el Iner para proyectar la Universidad hacia las regiones.
Sandra Turbay, alumna de Henao y, posteriormente, colega.
El antropólogo e investigador social
Hizo de la etnografía un eje fundamental. Empezaba a ser antropólogo desde que se planeaban los viajes de campo. Lo primero que hacía al llegar era reconocer la localidad o el lugar, entender la distribución espacial, iba a los mercados, iglesias, parques; miraba a la gente, sus rutinas, se fijaba en los recorridos que hacían, preguntaba dónde se reunían, iba a los colegios y hablaba con los más jóvenes.
Era muy preguntón, hacía unas observaciones muy interesantes, lanzaba caracterizaciones y promovía talleres en los que construía mapas, mapeaba, graficaba a las comunidades, a las familias y lo hacía con ellas, les pedía que dibujaran la percepción que tenían de los lugares, de la cultura, de los espacios, de esas territorialidades, también lo hacía con su equipo de investigación… Esa era su metodología de trabajo, muy cercana a las comunidades. Y leía sobre todo lo que observaba, porque era un gran lector, luego reelaboraba, repensaba y formulaba nuevas preguntas y les buscaba respuestas, partía de lo local para dar el salto a lo regional. Era feliz generando nuevo conocimiento, todo lo escribía con una soltura, las ideas que le iban surgiendo las volvía un texto.
Lucelly Villegas, colega.
7 N.º 686 · mayo de 2019 Universidad de Antioquia
Más de 1 140 000 colombianos con discapacidad visual tienen ahora a su alcance FarmaceuticApp, una novedosa herramienta digital que les facilitará usar adecuadamente sus medicamentos.
#INNOVACIÓNUDEA
FarmaceuticApp: reconocer medicamentos
sin
verlos
«¡Bip-bip, bip-bip, bip-bip!» Son las 11 p. m. cuando la alarma le recuerda que debe tomar su pastilla. La oscuridad invade la habitación. En la mesita de noche hay empaques de analgésicos, antiespasmódicos, antialérgicos y antibióticos. Aunque aletargado, usted consigue identificar el medicamento que le corresponde, y vuelve a dormir plácidamente.
La escena, sin embargo, no parece tan sencilla para todas las personas. Tal vez muy cerca de usted —en su mismo barrio o ciudad—, un invidente que debe tomar un medicamento no tenga las condiciones adecuadas para identificar la cápsula correcta. Equivocarse no solo implica que su tratamiento no funcione, sino también que pueda sufrir una intoxicación.
En Colombia hay más de un millón de personas con limitaciones visuales —las cifras más recientes son las del censo del 2005, realizado por el Dane—. A esta población va dirigida FarmaceuticApp, una aplicación gratuita para Android que está disponible en Play Store desde diciembre de 2018. El desarrollo fue diseñado en la Universidad de Antioquia para que personas con limitaciones visuales tengan la información necesaria para usar adecuadamente sus medicamentos.
Así funciona
La aplicación permite saber cómo usar los medicamentos, cómo almacenarlos, cuáles son sus efectos secundarios y otros
STIVEN ARIAS HENAO Periodista stiven.arias@udea.edu.co
consejos farmacéuticos. La clave de su éxito radica en sus cuatro formas de acceso: por lectura de código de barras, mediante reconocimiento de texto en imagen, con búsqueda por voz y a través de texto.
Según Juliana Madrigal Cadavid, todas esas opciones son importantes porque «alguien con discapacidad visual no sabe si su medicamento tiene código de barras o no», lo cual sería crítico si la aplicación solo contara con ese medio de acceso. La aplicación se originó en la investigación que Madrigal Cadavid realizó mientras cursaba la maestría en Ciencias Farmacéuticas y Alimentarias, y también como integrante del Grupo de investigación Promoción y Prevención Farmacéutica —P&PF—. FarmaceuticApp también permite buscar farmacias y hospitales cercanos con el GPS del celular e indica la ruta a seguir a pie o en vehículo, explicó Johan Granados Vega, investigador del grupo P&PF. Tales funciones, sumadas al TalkBack de Android —que traduce el texto de la pantalla a audio—, confieren al desarrollo una facilidad de uso sobresaliente, digna de un diseño pensado para esta población.
La información de la que dispone la aplicación proviene de una base de datos que construyeron los investigadores, la cual reúne información sobre aproximadamente 4500 medicamentos de distintas marcas y formas farmacéuticas —jarabes, tabletas, inyecciones y otras—, a partir de 450 principios activos. «Solo incluimos medicamentos de uso ambulatorio; no incluimos los de uso exclusivo hospitalario porque la idea no es que los pacientes se automediquen», recalcó Granados.

El desarrollo representa un ejemplo de la misión social que tiene la universidad pública colombiana con las poblaciones vulnerables del país. Así lo indicó Pedro Amariles Muñoz, vicerrector de Extensión de la Alma Máter. Como investigador del Grupo P&PF, Amariles dirigió la investigación que produjo la aplicación, «cuyo principal factor diferenciador es que responde a un proceso metodológico con rigor académico centrado en las necesidades del usuario», señaló.
Y ahora, ¿qué sigue para FarmaceuticApp?
Según Madrigal, sus diseñadores vislumbran que en una eventual nueva fase pueda incluir sistemas de recordatorios para la toma de medicamentos. Granados incluso se atrevió a soñar con que, a través de la aplicación, los usuarios puedan contactar al Centro de Información y Documentación de la Universidad de Antioquia —Cidua— para resolver sus inquietudes farmacéuticas.
8 N.º 686 · mayo de 2019 · Universidad de Antioquia
FarmaceuticApp está disponible en Play Store. Foto: Juan Pablo Hernández Sánchez.
Un antimicrobiano natural, a base de romero, inhibe el crecimiento de tres bacterias que pueden contaminar algunas carnes frías, lo que evita las graves afectaciones que esos microorganismos generan en la salud humana.
#INNOVACIÓNUDEA
Romero, blindaje natural para salchichas y mortadelas
Un mordisco es suficiente para que algún miembro de las ETA infecte su cuerpo. Puede sufrir desde afecciones gastrointestinales hasta complicaciones severas neurológicas, inmunológicas y ginecológicas, insuficiencia multiorgánica, cáncer o inclusive la muerte.
Las enfermedades transmitidas por alimentos —ETA—, son causadas por el consumo de agua y alimentos contaminados con bacterias nocivas como Listeria monocytogenes, Salmonella Typhimurium y Escherichia coli
Estos microorganismos patógenos, es decir, que causan enfermedades, están presentes en el agua, la tierra y la materia fecal humana y animal. Por su naturaleza, las carnes rojas y blancas, y las carnes procesadas como la salchicha, la mortadela, el jamón y el salchichón, se encuentran entre los alimentos que tienen un mayor riesgo de contaminarse y causar una infección por estas bacterias.

El blindaje antimicrobiano
En la industria de los alimentos cárnicos se usan antimicrobianos artificiales para inhibir el crecimiento de las bacterias, algunos de ellos, como el lactato de sodio, son efectivos en altas concentraciones y su aporte de sodio es muy alto.
Ante la necesidad de alternativas distintas a los antimicrobianos sintéticos, con la investigación «Efecto protector de un antimicrobiano natural frente a Listeria monocytogenes, Salmonella Typhimurium y E. coli en salchicha y mortadela», científicos de la Universidad de Antioquia y la Universidad Nacional evaluaron el crecimiento de estas bacterias usando un antimicrobiano natural que contiene extracto de romero.
«Los antimicrobianos naturales son ricos en compuestos químicos que pueden, entre otras cosas, oxidar el material genético y alterar la membrana de las bacterias. Cuando se combinan con otros extractos o sustancias naturales logran efectos sinérgicos. Se ha visto que el extracto de romero representa una actividad antimicrobiana en la carne y sus derivados», destacó Andrea Zapata Álvarez, miembro del Grupo de Agrobiotecnología de la Universidad de Antioquia y líder de la investigación.
Los investigadores inocularon en salchichas la bacteria E. coli y en mortadelas Listeria y Salmonella. Los productos se empacaron al vacío y se almacenaron en refrigeración, para analizar el crecimiento de estos microorganismos durante la vida útil comercial.
El antimicrobiano natural redujo en más del 50 % la población de E. coli y Listeria desde la segunda semana y en su dosis más alta a partir de la segunda y la tercera semana inhibió el 100 % de las bacterias. Solo se logró inhibir completamente la población de Salmonella al final del estudio en los productos con la concentración más alta de antimicrobianos.
«Concluimos que el antimicrobiano natural inhibe el crecimiento de la E. coli y Listeria. Sin embargo, su eficacia es muy limitada frente a la Salmonella», agregó Zapata Álvarez.
De la granja a las manos
Estas bacterias no se encuentran naturalmente en las carnes frías. La carne puede contaminarse en cualquier etapa, desde el corral en el que se engordan los animales hasta en la manipulación en las plantas de producción de carnes y durante su preparación y consumo. Por ello, son necesarias buenas prácticas de inocuidad en fincas, mataderos, industrias, transportes, puntos de venta y en la cocina.
JENNIFER RESTREPO DE LA PAVA Periodista jennifer.restrepo@udea.edu.co
«Interrumpir la cadena de frío permite que los microorganismos se proliferen en caso de estar contaminado el producto; congelar y descongelar acelera el proceso. El lavado de manos y la desinfección de los utensilios de cocina son muy importantes, la tabla de madera no es recomendable, en las líneas que

deja el cuchillo se aloja la Listeria y forma una película llamada biofilm para protegerse», señaló Nelly Ospina Debarreneche, especialista en Ciencia y Tecnología de Alimentos de la Universidad de Antioquia.
«Esto demuestra que muchos de los extractos naturales que usaban las abuelas para conservar alimentos realmente funcionan a escala industrial. Abre un panorama más amplio, teniendo en cuenta que algunos de los aditivos artificiales pueden acumularse en los tejidos y provocar enfermedades», reiteró la ingeniera biológica Andrea Zapata.
En la investigación también participaron los profesores Carlos Eduardo Mejía Gómez, miembro del Grupo de Biotransformación de la Escuela de Microbiología de la Universidad de Antioquia, y Diego Alonso Restrepo Molina, del Departamento de Ingeniería Agrícola y Alimentos de la Universidad Nacional de Colombia, Sede Medellín.

Las ETA afectan la salud, ocasionan una disminución en la productividad y el comercio y saturan los sistemas de salud.
Según el Instituto Nacional de Vigilancia de Alimentos y Medicamentos — Invima—, en Colombia ocurren cerca de 240 000 casos de infecciones transmitidas por alimentos al año.
9 N.º 686 · mayo de 2019 Universidad de Antioquia
Cultivo de E.coli. Foto: cortesía Escuela de Microbiología. Foto Andrés Londoño López.
Cultivo de Salmonella. Foto: cortesía Laura Castrillón Rojas.
Las salchichas son embutidos a base de carne picada, consumidos ampliamente en diversas preparaciones. Foto: Juan Pablo Hernández Sánchez.
Más de 100 millones de partículas de menos de un centímetro integrarían el gran basurero espacial. La falta de cooperación internacional, protocolos y financiamiento para enfrentar ese problema, ponen en riesgo el presente y futuro de las exploraciones espaciales.
#INVESTIGACIÓNAEROESPACIAL
Basura espacial, un reto para la ciencia
Cerca de 34 000 residuos de cohetes, satélites, naves y dispositivos derivados de misiones espaciales residen entre la órbita baja —entre los 400 y 2000 kilómetros— y la geoestacionaria —a aproximadamente 36 000 kilómetros— de la Tierra. Estos residuos giran a velocidades cercanas a 28 000 kilómetros por hora, lo que los convierte en proyectiles con capacidad de perforar naves, estaciones y trajes de astronautas. El impacto puede ser letal.
Para Juan Francisco Puerta Ibarra —colaborador del pregrado en Astronomía de la Universidad de Antioquia e investigador de la Universidad de Southampton—, ese número podría ser muy superior. «La cifra oficial, 34 000, corresponde al número de desechos que deben ser monitoreados por el Programa de Escombros Orbitales de la Nasa, en asocio con la Red de Vigilancia Espacial de Estados Unidos, ya que su tamaño es superior a 10 centímetros de diámetro. Sin embargo, se calcula que son más de 100 millones de partículas de menos de 1 centímetro las que están también en órbita».
Aunque no representa un problema medioambiental para la Tierra, el impacto de esta basura en satélites operacionales o vehículos espaciales tripulados puede ser desastroso. En agosto de 2017, 15 000 cajeros y terminales fijas de datos electrónicos dejaron de funcionar por varios días a causa de la falla del satélite indonesio Telkom-1, afectado por una nube de escombros.
La tecnología satelital permite que los dispositivos móviles tengan acceso a internet; monitorear los movimientos de mareas, huracanes, tormentas y otros fenómenos atmosféricos; también es clave para los dispositivos GPS.
La amenaza de colisión tiene en alerta a las empresas aeroespaciales e investigadores. «Se estima que los escombros espaciales combinados tienen una masa de 8000 toneladas», explicó César Ocampo Rodríguez, doctor en Astrodinámica, investigador de la Nasa y exdirector de Colciencias.
Ocampo Rodríguez resaltó que uno de los grandes problemas es la falta de cooperación internacional, protocolos y financiamiento para eliminar los objetos. Este no es un asunto de potencias económicas o de agencias espaciales; si falla un satélite, pueden verse afectadas varias regiones.
Remove Debris, programa del Centro Espacial de la Universidad de Surrey, lidera a escala global las estrategias de limpieza y remoción de escombros espaciales. Pero esta no es una tarea simple en un momento histórico en el que las exploraciones espaciales y la implementación de satélites van en ascenso.
Puerta Ibarra aseguró que «es más efectivo implementar alternativas que desde su origen calculen la desactivación y retirada de los dispositivos en órbita, para que luego no se tengan que recoger, como sucede con todos los fragmentos que han quedado desde que el hombre salió de la Tierra por primera vez». Sin embargo, el gran reto es recoger los escombros que hasta ahora se han generado.
PIEDRAHITA TAMAYO Periodista natalia.piedrahita@udea.edu.co

El coordinador del pregrado de Ingeniería Aeroespacial, Julián Mauricio Arenas Adarve, explicó que en la Universidad de Antioquia vienen avanzando en el modelo computacional DebRisk: Space Debris Risk Prospection and Assesment, una colaboración entre los programas de Ingeniería Aeroespacial y Astronomía, con el fin de tener una predictibilidad de los impactos sobre vehículos espaciales, que pueden generar los residuos de las actividades espaciales de los próximos años.
La sostenibilidad se piensa para el bienestar humano, pero la necesidad de una «ecología espacial» hace que se pongan en el tintero cuestiones que van más allá de los intereses de los gobiernos y las organizaciones.
La prioridad es eliminar los objetos más peligrosos de las órbitas más congestionadas. «Entre las estrategias de mitigación más efectivas se incluye evitar explosiones en órbita de satélites que se aproximan a su final de vida útil. Esto requiere eliminar los propelentes residuales para que los satélites no sean volátiles y evitar así colisiones de satélites aún operativos», explicó Ocampo Rodríguez.
¿Quiere ver la basura que orbita el planeta y su ubicación simulada? Escanee el código para acceder a la aplicación ASTRIAGraph, creada por Moriba Kemessia Jah, profesor e investigador del Departamento de Ingeniería Aeroespacial de la Universidad de Texas.

10 N.º 686 · mayo de 2019 · Universidad de Antioquia
NATALIA
El Programa de Escombros Orbitales de la Nasa monitorea cerca de 34 000 residuos. Intervención gráfica: Andrea Henao Jaramillo.
La Corte Constitucional les dio la razón a dos estudiantes de Economía que encontraron que el cálculo de la sobretasa a los combustibles líquidos no solo es inexacto, sino que también viola el principio de legalidad tributaria.
#INVESTIGACIÓNACADÉMICA
Con tesis de grado lograron revisión de sobretasa a la gasolina
Más que un requisito para optar al título de economistas, el trabajo de grado de David Jiménez Mejía y Víctor David Bernal Pavas tendrá impacto en el bolsillo de los colombianos, tengan o no automóvil.
Los jóvenes investigadores de la Facultad de Ciencias Económicas querían saber cómo han funcionado las políticas de estabilización del precio de los combustibles líquidos, entre ellos de la gasolina y el ACPM. El rastreo tuvo como punto de partida el año 2009, cuando se creó el Fondo de estabilización de los precios de los combustibles —FEPC—, y llegó hasta diciembre de 2016.
Con ese fondo, el Estado busca evitar que los incrementos inesperados en los precios internacionales de los combustibles se repliquen en los valores de venta al consumidor nacional. Las políticas de estabilización podrían explicar por qué cuando el precio internacional del petróleo cae, en Colombia los precios de la gasolina se mantienen e incluso, como sucedió en el 2015, a veces suben.
Para comprender el asunto, los investigadores analizaron el comportamiento y la composición de estos precios, que se denominan tarifarios. Es decir que se componen de varias tarifas, que al sumarse resultan en el precio final que se cobra en los surtidores. Una buena parte, casi el 55 % del valor en las estaciones de servicio, corresponde al ingreso al productor, que es el que recibe el refinador o importador del combustible en Colombia, por ejemplo Ecopetrol.
El precio misterioso
Jiménez y Bernal encontraron dos preocupaciones en el camino. La primera, que la forma de cálculo del ingreso al productor, que se establece mes a mes por parte del Ministerio de Minas y Energía, no sigue una metodología estricta y lo hace de manera discrecional, según
JUAN DIEGO RESTREPO TORO Periodista juan.restrepo16@udea.edu.co
lo que estime el mismo Ministerio. La otra, que la base gravable sobre la cual se fija la sobretasa a la gasolina también carece de parámetros definidos y claros.
Es decir que la sobretasa, que corresponde a un porcentaje del precio de mercado, es definida arbitrariamente por el Ministerio. «El principal problema es que ese porcentaje no se está cobrando sobre el precio de referencia del mercado, sino sobre un precio artificial y por encima», explicó Bernal Pavas.
Este impuesto es tan importante que incide en el precio de los alimentos y del transporte público en el país. Además, mega-obras como el Metro de Medellín o el futuro metro de Bogotá, son financiadas con él.
A partir de estos hallazgos, Jiménez Mejía, quien además de economista es abogado, presentó una demanda en septiembre del 2017, alegando ante la Corte Constitucional que esta forma de cálculo era inconstitucional porque violaba el principio de legalidad tributaria, que implica que solo los organismos de representación popular pueden imponer tributos.
La Sala Plena de la Corte Constitucional, mediante la sentencia C-030/19, declaró inconstitucional el artículo 121 de la Ley 488 de 1998, que definía que la base gravable «está constituida por el valor de referencia de venta al público de la gasolina motor tanto extra como corriente y del ACPM, por galón, que certifique mensualmente el Ministerio de Minas y Energía». Además, ordenó que le corresponde al Congreso Nacional y no al Ministerio, la responsabilidad de establecer los criterios específicos del cobro, en un plazo no mayor a dos legislaturas. «Ahora será interesante observar cómo se dará esa discusión en el Congreso —señaló David Jiménez Mejía—. Hay que dejar de administrar los precios de los combustibles, si vamos a hablar de una política de regulación, que sea seria, que tenga criterios objetivos y que cualquier ciudadano pueda saber cómo se calcula ese precio».

Aunque los estudiantes estuvieron a punto de desistir de su investigación porque les fue difícil acceder a los datos, su tesis fue laureada por el jurado académico. Sin embargo, la sentencia le dejó un sinsabor a Jiménez. «Al otro día e este fallo, los precios de los combustibles debieron haber caído, si la decisión hubiera tenido efecto inmediato. Pero como la Corte moduló los efectos del fallo y le dio dos años al Congreso para legislar, mientras tanto los contribuyentes tenemos que seguir pagando esa sobretasa que fue declarada inconstitucional».
Por ahora los precios al consumidor final no van a cambiar y habrá que esperar que el Congreso establezca la nueva forma del cálculo. Sin embargo, Jiménez y Bernal —recién graduados como economistas— esperan que su tesis se traduzca en un alivio para el bolsillo de las familias colombianas.
11 N.º 686 · mayo de 2019 Universidad de Antioquia
Infografía: Mónica Valencia Arismendy.
Hay libélulas especialistas en ríos, pantanos, cascadas y plantas. Llevan 400 millones de años volando por el planeta, por lo que son potentes indicadores del equilibrio ecosistémico. Colombia tiene cerca de 500 de las 6000 especies identificadas.
#UDEACIENCIA
NATALIA PIEDRAHITA TAMAYO Periodista natalia.piedrahita@udea.edu.co
Maestras de la velocidad
Cuando los dinosaurios habitaron la Tierra, hace aproximadamente 240 millones de años, las libélulas ya volaban en bosques y sobre cuerpos de agua. A través del tiempo han presenciado las transformaciones planetarias, convirtiéndose en las más longevas maestras del vuelo en este planeta.
Se les conoce con apelativos como «achicapozo», «helicópteros» y «caballitos del diablo» y por su morfología han estado unidas a la simbología de diferentes culturas. Para los aztecas, por ejemplo, encarnan la pureza del agua, por lo que eran representadas como compañeras de Tlálloc —dios de la lluvia—, en sus jornadas de cantos y juegos.
En Colombia viven cerca de 500 de las 6000 especies de libélulas que se conocen en el mundo. En la región de los Andes, una de las más diversas y exploradas del país, se encuentran alrededor de 250 especies y en su vertiente occidental, lugar de confluencia de la biota centro y suramericana, está cerca del 30 % de la diversidad de las libélulas en el país. En los últimos años el profesor Cornelio Bota Sierra, investigador del Laboratorio de Entomología de la Universidad de Antioquia, ha descrito 12 nuevas especies en el territorio nacional.
Heteragrion tatama, Cora verapax, Philogenia martae, Archaeopodagrion fernandoi, son cuatro nuevas especies que Bota Sierra encontró en la zona cercana al Parque Nacional Natural Tatamá, ubicado en el piedemonte chocoano de la cordillera Occidental. «Su capacidad de adaptación es tal, que algunas especies pueden vivir en aguas sedimentadas o en bosques intervenidos por el hombre; pero otras no soportan las intervenciones humanas, entonces se extinguen local o totalmente y, por ello, su presencia indica con certeza la historia y salud de un ecosistema», explicó el investigador, quien ha dedicado a las libélulas su trabajo académico.
El aspecto frágil, las largas alas y el colorido de su cuerpo guardan la memoria genética que les ha permitido sobrevivir ante las transformaciones del entorno. Son diurnas y de tamaño pequeño; dependiendo de su ubicación geográfica y morfología, viven entre tres meses, en zonas tropicales, o hasta cinco años, en los duros climas árticos. En el caso de los individuos que habitan en Colombia, el promedio está entre seis meses y un año.
«Dado que las libélulas son cazadoras durante todo su ciclo de vida, su diversificación se

debe a la especialización de sus larvas e individuos adultos a diferentes hábitats. Su relación con el lugar habitado es tan estrecha, que si este se modifica es posible que se extingan, por ello existen especies que indican la buena salud de un cuerpo de agua o un bosque, y otras que son fieles a espacios intervenidos por el hombre como potreros o cultivos», señaló Bota Sierra, quien participó en una publicación sobre el estado de conservación y distribución de la biodiversidad en los Andes tropicales, en la que se evaluaron 216 especies endémicas de esta región.
Colombia, rica en libélulas
Las investigaciones sobre libélulas le han mostrado a Bota Sierra la urgencia de desmontar la idea generalizada de que la biodiversidad del país está mayoritariamente en las selvas del Amazonas y el Chocó, es en los Andes

donde reside buena parte de las especies del continente: «Cada 500 metros altitudinales hay cambios en las especies del orden odonata paleópteros que no pueden plegar sus alas y en su mayoría extintos, por lo que ostentan la historia evolutiva más larga entre los animales voladores—, debido a ello, las comunidades que viven en Colombia son muy diversas, incluso más que las amazónicas».
Cada libélula es guardiana de su lugar, entonces se encuentran en páramos, bosques, ríos, pantanos; allí cazan y se reproducen para darle continuidad a la especie. En el Chocó y el Magdalena Medio vive el ejemplar de envergadura alar más grande del mundo: Megaloprepus caerulatus, una cazadora de arañas de hasta veintidós centímetros, que se pasea por pantanos, zonas selváticas y ríos.
Esta especie está estrechamente ligada a bosques conservados, pues sus larvas solo se


12 N.º 686 · mayo de 2019 · Universidad de Antioquia
La Mesamphiagrion santainense es una de las especies altoandinas amenazadas. Foto: cortesía Cornelio Bota Sierra.
Diversas especies de libélulas colombianas registradas por el investigador
Cornelio Bota Sierra. De izquierda a derecha: Diastatops obscura, Hetaerina occisa
velocidad y el vuelo

desarrollan en pocetas de agua que se forman en los troncos de los árboles más grandes, en algunos casos mientras están vivos. Debido a esto, cada vez que cae un árbol, los machos de esta especie vuelan sobre el tronco, reconociendo el territorio en el que probablemente podrá vivir su próxima generación. Por esto, los aserradores las conocen como «maestras», ya que la libélula vuela sobre el tronco talado supervisando si el trabajo quedó bien hecho.
Algunas especies altoandinas descritas por Bota Sierra están amenazadas, según las ha declarado la Unión Internacional para la Conservación de la Naturaleza. Ellas son la Mesamphiagrion gaudiimontanum, Mesamphiagrion nataliae, Mesamphiagrion rosseri, Mesamphiagrion santainense y Oxyallagma colombianum, que luchan por sobrevivir en ecosistemas cercanos a los principales asentamientos humanos de nuestro

país, como la sabana cundiboyacense y el Valle de Aburrá.
«El hacha que mis mayores me dejaron por herencia nos está acabando», enfatiza Bota Sierra, quien reivindica el carácter fundamental de los bosques en la vida de los insectos: «Tenemos un rasgo cultural que nos lleva a acabarlos. Puedes tener el agua más pura del mundo, pero si tumbas un bosque, algunos grupos de libélulas se extinguirán».
Ágiles y con potente visión
Otro de los talentos de estas ninfas aladas es la capacidad de transmitir la información velozmente a sus músculos, quizá una de las razones de su éxito evolutivo. Bota Sierra narró que los sistemas oculares de las libélulas son investigados por el ejército de Estados Unidos para develar la velocidad a la que pueden reaccionar frente a estímulos visuales. «Después de


conectar electrodos en su sistema neuronal, las encierran, luego sueltan abejas y moscas como presas, para grabar el comportamiento de la libélula ante ellas y su transmisión de impulsos nerviosos. Al reproducir los videos en cámara lenta, aprecian cómo logran agarrar fácilmente a sus víctimas con pocos movimientos». Pero la sensibilidad de las libélulas va más allá de la visión, su vuelo es todo un arte: para su tamaño son el insecto con mejores maniobras en la naturaleza. En el caso de las moscas, por ejemplo, aunque tienen excelentes maniobras, su tamaño es inferior, por lo que no podría establecerse una comparación.
Otros de los hallazgos de Bota Sierra son la Oxyallagma colombianum y la Rhionaeschna caligo, en el Páramo de Belmira, e Inpabasis nigridorsu y Diaphlebia richteri, en la Amazonía. A partir de sus indagaciones el investigador advierte que «la sensibilidad de las libélulas y su relación con el entorno es un recordatorio de que la fragilidad de la vida es la base del cambio».
Las investigaciones sobre las libélulas en Colombia son escasas. Para desarrollar su trabajo Bota Sierra acudió al conocimiento de expertos de otros países como Rosser Garrison, Natalia von Ellenrieder y Jürg De Marmels. El Laboratorio de Entomología de la Universidad de Antioquia custodia 6368 ejemplares de libélulas.
En 1916, los naturalistas Edward y Jesse Williamson se internaron en la región del Magdalena Medio y recolectaron 8553 especímenes de libélulas que depositaron en el Museo de Historia Natural de la Universidad de Michigan (Williamson 1918). Más tarde, en 1938, Apolinar María, lasallista francés, publicó el primer catálogo de odonata para Colombia, pero su colección se quemó en El Bogotazo, en 1948. Por muchos años el tema estuvo prácticamente inexplorado, hasta que se creó el Grupo Colombiano de Odonatología, que desde la década pasada ha realizado diversos trabajos sobre conservación, ecología y evolución.
13 N.º 686 · mayo de 2019 Universidad de Antioquia
occisa, Mesamphiagrion gaudimontanum, Perithemis mooma y Mesagrion leucorrhinum
Diariamente mueren 830 mujeres embarazadas en el mundo por causas relacionadas con el embarazo, el parto y el posparto. Un estudio sugiere que en Antioquia pueden morir más madres por suicidio que por complicaciones obstétricas.
#SALUDMATERNA
STIVEN ARIAS HENAO Periodista stiven.arias@udea.edu.co
Suicidios durante el embarazo, un tema que pide atención
«¡Lo sentimos! Hicimos todo lo que pudimos, pero… falleció». Una frase, un instante de hielo, un torrente de melancolías. Nadie, absolutamente nadie quiere confrontar la mirada del médico que, cual heraldo de la muerte, confirma el deceso de un ser querido. Sin embargo, el trauma es mayor si se trata del suicidio de la mujer que hace poco estrechaba en su seno al fruto de su vientre. Sí, hay muertes de muertes. Generalmente la «muerte materna» —es decir el fallecimiento de una mujer durante su embarazo o hasta 42 días posparto— es asociada, por ejemplo, con la hemorragia posparto, que es la primera causa a nivel mundial. Pero un estudio del grupo de investigación y extensión Nacer, Salud Sexual y Reproductiva, de la Universidad de Antioquia, halló que entre 2004 y 2014 se presentaron 24 suicidios maternos en Antioquia, superando las 11 muertes por sepsis o infección obstétrica.
Gladis Adriana Vélez Álvarez, coordinadora del grupo Nacer —de la Facultad de Medicina—, dijo que esos 24 suicidios constituyen el 4.8 % del total de muertes maternas ocurridas durante los diez años. La cifra representa un porcentaje considerable para una realidad que apenas se está
dimensionando, pues hasta el año 2012 la Organización Mundial de la Salud —OMS— no relacionaba el suicidio directamente con la muerte materna, sino que la consideraba una causa externa.
El estudio halló que la mayoría de las mujeres que cortaron su vida, aun ante la perspectiva de ver crecer a sus hijos, tenían entre 15 y 24 años de edad. De acuerdo con Natalia Aguirre Martínez, especialista en Ginecología y Obstetricia que participó en la investigación, la mayoría no eran bachilleres, vivían en zonas rurales y tenían bajo nivel socioeconómico.
La amarga paradoja del suicidio materno deja a muchas familias sin la resiliencia necesaria para sobreponerse al impacto, por lo que algunas se desintegran, señaló Vélez. Gloria Patricia Peláez Jaramillo, docente del Departamento de Psicología de la Alma Máter, reconoció que el papel de las madres pasa por brindar apoyo, seguridad y acompañamiento a su núcleo. Cuando no está, esos roles se ven afectados y la dinámica familiar se desestabiliza, aunque en ocasiones otra figura puede suplir tales facetas.
Los investigadores de Nacer esperan que el tema del suicidio materno quede definitivamente instaurado en la mesa de las autoridades en salud en Colombia, y que la salud mental de las mujeres en gestación sea incluida en los controles prenatales y posparto, como ocurre con las valoraciones nutricionales y odontológicas.
SERGIO ALEJANDRO RUIZ SALDARRIAGA Periodista salejandro.ruiz@udea.edu.co
En los últimos años, diversas unidades de obstetricia de Medellín han cerrado por falta de demanda para sostenerlas. Una investigación realizada por la Universidad de Antioquia reveló algunas problemáticas que impactan los servicios de partos en la ciudad.
Servicios maternos, un parto con complicaciones
Contracciones, dolor abdominal y sangrado. Esas son las alertas que habitualmente le indican a una futura madre que debe prepararse para el parto. Ese procedimiento —que médicamente es tan común—, es hoy, sin embargo, uno de los puntos críticos del sistema de salud en Medellín: desde hace varios años hay una disminución considerable de las unidades de obstetricia y cada vez son más altos los costos para atender el procedimiento de manera integral. Clínicas como El Sagrado Corazón, Las Vegas, Comfenalco y la IPS Universitaria son algunas de las instituciones que en los últimos años han cerrado sus unidades de atención de partos en Medellín. Algunas de ellas debido a problemáticas como el bajo volumen de
atenciones, la capacidad de sostenimiento del servicio, la tarifa que reconocen los pagadores frente a los costos de la atención y las constantes exigencias normativas del sistema.
Y aunque el panorama de cierres parece estar controlado, pues en el último año no se han presentado cierres definitivos de otras unidades, las preocupaciones que tienen en cuidados intensivos a este tipo de servicios llevaron a que la Secretaría de Salud de Medellín convocara a la Universidad de Antioquia para analizar esta situación e investigar el desbalance entre el costo del parto y la tarifa que reciben los prestadores por este servicio.
De dicho convenio surgió el estudio Análisis del costo de la atención del parto
en Medellín , presentado en el 2016 y siendo el más reciente que existe sobre el tema. La investigación evidenció que «el costo de un parto no se puede entender solo desde lo netamente asistencial, pues este proceso incluye costos asociados para una atención integral», según explicó Paula Castro García, profesora de la Facultad de Ciencias Económicas de la Alma Máter.
La investigación realizada por el Grupo Economía de la Salud —GES—, de la Facultad de Economía, y el grupo Nacer, de la Facultad de Medicina, convocó a seis instituciones prestadoras de salud a participar, pero solo tres de ellas —que concentran el 33 % de los partos de la ciudad— aceptaron brindar información.
14 N.º 686 · mayo de 2019 · Universidad de Antioquia
Convenio por la salud sexual y reproductiva
A través de Nacer, la Universidad de Antioquia será una aliada estratégica de la oficina para América Latina y el Caribe del Fondo de Poblaciones de las Naciones Unidas. Nacer desempeñará tareas claves en sintonía con el cumplimiento de los objetivos estratégicos del Fondo para la región en tres temas fundamentales: anticoncepción, salud materna y prevención de la mortalidad.
«Tenemos el reto de conformar un grupo de trabajo con otras instituciones que lidere el tema de la anticoncepción en la región. Vamos a desarrollar cursos para la capacitación o entrenamiento de formadores de la región en este tema, básicamente profesores universitarios y proveedores de servicios de salud», explicó Vélez.
El grupo desarrollará asesorías técnicas en salud materna y en prevención y vigilancia de la mortalidad materna en países como República Dominicana, Paraguay y Panamá. El convenio también representa una puerta abierta para que otros grupos de investigación de la Universidad puedan articularse con las Naciones Unidas en futuros trabajos.
Además de identificar el costo ideal de un parto en la ciudad, la tendencia a la reducción del número de partos fue notoria, generando así una reacomodación de la oferta por este servicio. Dentro de la investigación se plantean algunos retos importantes a tener en cuenta, como que la atención de partos es un servicio de volumen que solo es posible sustentar a partir de una demanda considerable y garantizada.
También aparecen como punto crítico los manuales tarifarios. Los prestadores de salud negocian la tarifa del servicio eligiendo alguno de los tres manuales tarifarios con los que cuenta el país: ISS 200, ISS 2001 y Soat. Los dos primeros fueron diseñados por el extinto Instituto del Seguro Social; el último, pensado para la atención de accidentes de tránsito.
Para Sandra Vélez Cuervo, jefe del Departamento de Ginecología y Obstetricia de la Facultad de Medicina, es necesario reevaluar la vigencia de las tarifas actuales, teniendo en cuenta que se han modificado los protocolos de atención para el cuidado de la población gestante, que incluyen unos mínimos de atención distintos a los establecidos hace 19 años por la Resolución 412 del Ministerio de Salud.
Entre 2004 y 2006 morían cada año alrededor de 60 madres antioqueñas por cada 100 mil bebés nacidos vivos. En 2017 fueron 21. Para dicha reducción fue clave la implementación de Código Rojo, protocolo de capacitación al personal de salud para la atención de las pacientes con hemorragia posparto desarrollado por Nacer, indicó Vélez.
Según el Análisis de la Situación de Salud —Asis—, Colombia, 2017:
Diariamente ocurren 830 muertes maternas en el mundo.
Los departamentos colombianos con más muertes maternas son Chocó, Vichada, La Guajira, Córdoba, Guainía, Vaupés y Putumayo.
En 2016, las cifras más altas de mortalidad materna en Colombia se concentraron en poblaciones vulnerables, como indígenas o afrodescendientes.
El artículo «Mortalidad por suicidio relacionado con el embarazo en Antioquia (Colombia), 2004-2014» está disponible para consulta en la Revista Colombiana de Obstetricia y Ginecología.
Ruta integrada de atención, la cura Desde 2016, Colombia cuenta con la Política de Atención Integral en Salud —Pais— que busca la transformación del modelo al que pertenece la ruta integrada de atención maternoperinatal, la primera de estas firmada por el Ministerio de Salud.
La ruta le apunta al mejoramiento del servicio mediante su implementación, permitiendo una oportuna clasificación de las maternas para que su atención se dé en la institución más adecuada, según su caso y los profesionales que necesita.
«Esta es una concepción que las pacientes aún no tienen, ya que desde el embarazo desean atender su parto en clínicas que no necesariamente corresponden al nivel de complejidad de su procedimiento», precisó Vélez.
Uno de los mayores retos es implementar nuevos procesos de renegociación entre las entidades aseguradoras de salud y las instituciones que prestan el servicio, teniendo en cuenta el costo real de procesos como el parto, pues tanto la investigadora Castro como la ginecobstetra Vélez, coinciden en que se debe encontrar un balance entre los costos y la complejidad de atención, buscando que estos servicios sean autosostenibles y, así, evitar próximos cierres de estas unidades.

15 N.º 686 · mayo de 2019 Universidad de Antioquia
Entre 2004 y 2014 se presentaron 24 suicidios maternos en Antioquia. Foto: Cortesía Leonardo Guzmán Giraldo.
Debido a la alta carga contaminante del asfalto de refinería, las mezclas asfálticas naturales son hoy alternativa ecológica. Investigadores del grupo PFA de la Universidad de Antioquia estudian este material, utilizado también en algunas obras de infraestructura universitaria.
#UDEASOSTENIBLE
NATALIA PIEDRAHITA TAMAYO Periodista natalia.piedrahita@udea.edu.co

Mezclas asfálticas naturales para la salud del planeta
La alarma ante la contaminación del agua y el aire, y la incidencia de estos elementos en la salud de las personas y ecosistemas, pone a prueba también al desarrollo de infraestructura vial. Ante ello, muchas compañías constructoras están recurriendo a las mezclas asfálticas naturales, un material sostenible, ecológico y económico, que surge de un proceso de extracción que no requiere explosivos, no involucra procedimientos en caliente y tampoco requiere consumos energéticos mínimos.
La investigadora Gloria María Restrepo Vásquez, directora del grupo de Procesos Fisicoquímicos Aplicados —PFA— de la Universidad de Antioquia, explicó que «el componente principal de estas mezclas es la asfaltita que, al ser una mezcla formada por la naturaleza con cualidades intrínsecas, permite el almacenamiento durante tiempos prolongados y se diseña para una vida útil superior a 10 años».
Desde el año 2013, el grupo PFA ha liderado investigaciones y proyectos para contribuir en la solución de necesidades relacionadas con la conectividad regional y nacional de Colombia, a través de materiales alternativos para infraestructura vial y mediante la ejecución de varios proyectos financiados por distintas entidades del orden nacional, tanto públicas como privadas.
De hecho, la Universidad de Antioquia ha empezado a utilizar este tipo de mezclas asfálticas en proyectos de infraestructura en sus sedes educativas. Recientemente se dio la instalación de 2200 m² —93 celdas— de parqueadero vehicular en la Ciudadela de Robledo con esta mezcla asfáltica, pensando en transformar dicho espacio en aras de la sostenibilidad.
«Al ser una técnica en frío o temperatura ambiente, y al obtenerse desde su fuente natural, no requiere de agua para la aplicación y se ahorra el gasto energético para la preparación del material. Por ello, se plantea como alternativa ante los retos medioambientales que actualmente se enfrentan», explicó Edgar Peña Acosta, especialista en vías terrestres.
En diciembre de 2017 el Instituto Nacional de Vías —Invias— emitió la Resolución 10099, por la cual se aprobó el uso del asfalto natural en todo el territorio colombiano y se estipularon
las especificaciones para construcciones y pavimentaciones con este material en vías con bajos volúmenes de tránsito.
En Colombia hay cuatro minas a cielo abierto con permisos legales para la extracción del material: San Pedro, en Armero, Tolima; La Milagrosa, en Norcasia, Caldas; la de asfaltita, en Pesca, Boyacá; y la mina Moan, en El Paujil, Caquetá. Todas cuentan con los avales para la extracción de esta mezcla, que se realiza con una retroexcavadora que arranca el asfalto de la tierra sin necesidad de agua.
Alternativa ecológica
En el mercado existen las mezclas asfálticas en frío, lechadas o tratamientos superficiales, y también las mezclas en caliente. Estas últimas son las de uso más común en el mundo y se producen con agregados pétreos y asfalto de refinería, es decir, del residuo de la depuración del crudo de petróleo, un proceso de destilación y obtención que impacta el suelo, contamina el agua y depende de un gran consumo energético para la extracción del crudo de petróleo.
Las empresas que utilizan el petróleo para generar sus productos son agentes del desgaste ambiental, y la participación de este en el sector de la construcción de carreteras es alta, ya que es el principal componente. Su extracción es una amenaza para los cuerpos de agua y ecosistemas, sin embargo, la infraestructura vial es determinante para el desarrollo económico de los países.
Como la depuración del crudo de petróleo es la base de las mezclas asfálticas en caliente, y esta es la de mayor uso en el mundo, es necesario recurrir a grandes cantidades agua, por ello algunos expertos han hecho llamados para volcarse a alternativas como la mezcla asfáltica fría, que no solo facilita la instalación, sino que ofrece excelentes terminados y permite mantenimientos rutinarios y periódicos.
Pero la conveniencia de este asfalto no solo tiene que ver con su sostenibilidad medioambiental, sino que, además, es menos deformable a los cambios de temperatura, que son usuales en diferentes regiones del país en las que el clima pasa del frío al calor intenso y de épocas de lluvias a sequías temporales.
16 N.º 686 · mayo de 2019 · Universidad de Antioquia
Esta vía, en San Martín, departamento del Cesar, fue construida con mezcla asfáltica natural. Foto: cortesía Edgar Peña Acosta
Por sus componentes y tamaño, las llantas son uno de los residuos tóxicos más problemáticos del mundo. Investigaciones de estudiantes de pregrado y posgrado buscan su aprovechamiento para generar asfalto y baldosas con características especiales.
#INVESTIGACIÓNAPLICADA
RESTREPO DE LA PAVA Periodista jennifer.restrepo@udea.edu.co
De residuo peligroso a cemento flexible
Cada año se desechan alrededor de 400 millones de llantas en el mundo, se calcula que solo la mitad de ellas son recicladas. Es decir, año tras año, queda a la deriva en el planeta una cantidad de estos desechos similar al número de habitantes de Brasil —208 millones de personas—.
Por ello, investigadores de la Universidad de Antioquia reutilizan estos residuos con el fin de explorar nuevas aplicaciones para la fabricación de asfalto y baldosas, lideradas por el profesor Henry Colorado, director del grupo CCComposites de la Facultad de Ingeniería. El polvo, el grano y los trozos pequeños de caucho de llantas recicladas se convierten en la materia prima del cemento de caucho.
«Con estos polvos procesados a escala industrial fabricamos baldosas a base de caucho y probamos distintas aplicaciones. Usamos diversas concentraciones, distribuciones y tamaños de partículas. Gracias al trabajo en conjunto con la empresa Prismacaucho y al apoyo del ingeniero Juan Carlos Salazar, creamos una fórmula para tener baldosas más delgadas y flexibles. Les realizamos pruebas físicas, químicas y, a partir de los resultados, hemos realizado diversas publicaciones en revistas científicas», destacó Carlos Fernando Revelo Huertas, ingeniero químico y estudiante de la Maestría en Ingeniería de Materiales de la Universidad de Antioquia. Para obtener granos y polvo de caucho, se retira el material metálico de la llanta y el caucho pasa por molinos de trituración primaria y secundaria. Las características del polvo permiten que sea usado en múltiples aplicaciones, como mezclas de asfalto, y para mejorar otras propiedades.
«Diseñamos baldosas de caucho para ambientes que requieren mayor resistencia, como escenarios deportivos, gimnasios, parques de juego o jardines infantiles, además reduce el impacto ante un golpe. Son versátiles, fáciles de

instalar y se adaptan al ambiente gracias al uso de resinas de alto rendimiento con fibras o partículas», agregó Revelo.
Los experimentos realizados en la investigación demostraron que usar llantas recicladas para la fabricación de cemento constituye un proceso económico y fácil de escalar a la industria, que requiere de gran cantidad de neumáticos, lo que beneficia al medio ambiente y aporta a la economía.
La investigación obtuvo el primer premio en la categoría «posters» del encuentro anual de la Sociedad de Minerales, Metales y Materiales, TMS 2019, en San Antonio, Texas.

El problema, parte de la solución
Las llantas que se fabrican con caucho, acero y químicos como el petróleo y el azufre, tardan entre 100 y 400 años en biodegradarse. La Unión Europea incluyó a las que están fuera de uso en la lista mundial de residuos tóxicos y peligrosos.
Su desecho inadecuado está relacionado con problemas de salud pública y efectos ambientales y económicos adversos asociados a la contaminación. Acumulan agua y son criaderos de mosquitos transmisores de enfermedades; obstaculizan y alteran los caudales de ríos y quebradas, desencadenando deslizamientos e inundaciones.
Si una llanta está sumergida por mucho tiempo, los químicos solubles afectan la fauna y la flora hídrica. Cuando están secas son altamente inflamables, si se queman el humo se esparce en el ambiente y transporta gases tóxicos.
Este residuo representa desafíos para los gobernantes y la industria de la ingeniería colombiana. Por esta razón, desde sus aulas, la Universidad incentiva la búsqueda de soluciones efectivas para minimizar la cantidad de llantas y crear un impacto positivo en el medio ambiente.
Entre las investigaciones para el aprovechamiento de las llantas, han surgido experiencias como la de EcoReproducts, que pasó de ser un trabajo de grado de Ingeniería de Materiales a un emprendimiento. Fabrican pisos flexibles con superficies seguras que se pueden usar en una guardería o en un establo.
EcoReproducts pasó de ser un trabajo de grado a un emprendimiento que produce pisos flexibles a partir de llantas y excedentes industriales. Foto: cortesía EcoReproducts.
«Queríamos aprovechar un residuo como las llantas, transformarlas y ofrecer un producto innovador. Diseñamos, fabricamos y comercializamos pisos flexibles a partir de llantas y excedentes industriales de otros procesos del caucho», enfatizó Víctor Hugo Ospina, ingeniero de materiales egresado de la Alma Máter de los antioqueños y gerente general de EcoReproducts.
Científicos de todo el mundo exploran el reciclaje de llantas para fabricar, además, césped artificial, sandalias, zapatos, obras de arte, artesanías, muebles, adoquines, hormigón, morteros, señales de tránsito, topes de estacionamientos, impermeabilizantes, entre otros.
Cerca de 1.4 mil millones de llantas nuevas se venden al año en el mundo.
Se calcula que en los vertederos de basura se almacenan cerca de 4 mil millones de neumáticos de desecho.
En Colombia, la Resolución 1326 del Ministerio de Medio Ambiente establece sistemas de recolección selectiva y gestión ambiental de las llantas usadas y se dictan otras disposiciones.
17 N.º 686 · mayo de 2019 Universidad de Antioquia
JENNIFER
Foto: cortesía EcoReproducts.
Viajan en el agua hasta lo ríos y mares. Los macro y microplásticos invadieron el sistema circulatorio del planeta y hoy son una de las enfermedades de la Tierra.
#CRISISAMBIENTAL
NATALIA PIEDRAHITA TAMAYO Periodista natalia.piedrahita@udea.edu.co
La invasión del plástico
Alrededor de un millón de aves y cien mil mamíferos marinos mueren anualmente por los plásticos que llegan al mar. Las zonas costeras y marinas son el destino final de las actividades humanas que involucran macroplásticos y microplásticos; estos últimos se convierten en transporte de diferentes agentes contaminantes de los organismos vivos.
«En las poblaciones costeras de Colombia, las aguas residuales entran al mar sin tratamiento previo, incluso en grandes ciudades como Santa Marta y Cartagena», enfatizó la investigadora de la Sede de Ciencias del Mar de la Universidad de Antioquia, Mónica María Zambrano Ortiz. Pesticidas, hidrocarburos, metales y microorganismos son los contaminantes que han sido monitoreados por la Red de Vigilancia para la Conservación y Protección de las Aguas Marinas y Costeras de Colombia —Redcam—. Dicha red, a partir de la cual se lideran iniciativas para la conservación de las aguas del país, es coordinada por el Instituto de Investigaciones Marinas y Costeras —Invemar—, en asocio con las corporaciones regionales.
Los macroplásticos son principalmente envases, bolsas y recipientes. Los elementos que miden menos de cinco milímetros son considerados microplásticos. «Estos son partículas que ingresan al agua porque no todos los países tienen plantas depuradoras capaces de deshacerlos. Los plásticos grandes se van desintegrando con el paso del tiempo, pero mientras eso sucede, destilan sus componentes en el medio marino», explicó Zambrano Ortiz. La vida útil del plástico oscila entre los 50 y los 600 años, dependiendo de sus componentes. Sin embargo, en el medio marino su degradación se hace más compleja: además, en las zonas costeras la fricción hace que los plásticos grandes se desintegren y deriven en microplásticos.
Los animales más afectados son las aves, que al tratar de cazar peces, ingieren plástico que luego llevan a sus polluelos. En mamíferos marinos, como las tortugas, se observa que los plásticos se adhieren, adquiriendo la forma del intestino e impidiendo que puedan eliminarlo, por lo cual mueren de dolor y hambre. Otros organismos, como peces y tiburones, mueren asfixiados porque confunden las bolsas con medusas, y en el caso de los pólipos de corales, son taponados a menudo por macro y microplásticos.
Greenpeace estima que la contaminación por plástico en el mar puede ascender a 12 millones de toneladas métricas por año, con mayor concentración en zonas como la isla de basura del Pacífico, equivalente en área a Francia.
Según Fernando José Parra Velandia, investigador de la Sede de Ciencias del Mar de la Universidad de Antioquia, «el problema es mayor: las partículas pequeñas operan como una esponja que absorbe componentes tóxicos, que van a parar a los organismos marinos, y posteriormente a todos los animales de la cadena trófica incluido el humano». Desde afecciones estomacales y cutáneas, hasta cánceres, son asociados a la ingesta de altas concentraciones de contaminantes, como el petróleo derramado por buques; y el mercurio esparcido por minería ilegal.
Algunos compuestos son tan peligrosos que han alertado especialmente a las autoridades de salud y ambientales: «El planeta es un sistema en el que todo está conectado, pero no lo creemos así. Existe un compuesto llamado Bisfenol-A, presente
en derivados del plástico, que llega principalmente por el agua, altera el sistema endocrino y las hormonas, es muy perjudicial para la salud humana, casi todos los países están trabajando en erradicarlo», advierte Zambrano Ortiz.
El reciente cobro de bolsas establecido por el Ministerio de Medio Ambiente y Desarrollo Sostenible es una medida que surge ante la alarmante contaminación del planeta, sin embargo, muchos la consideran poco efectiva. La esperanza emerge desde las iniciativas locales, como en los municipios de Iza y Nobsa, en Boyacá, donde se están reemplazando los plásticos por empaques biodegradables; y en Santa Marta se erradicó el poliestireno expandido de un solo uso —también conocido como «icopor»—. Además, a través de la Resolución 1407 de 2018, se incentiva el aprovechamiento de los residuos para proyectos de innovación y generación de ecoempaques.
En Urabá, sede de estudios marinos de la Universidad de Antioquia, se están desarrollando diferentes investigaciones sobre la incidencia de los plásticos en peces y para que la comunidad del Golfo gestione los residuos para la sostenibilidad de sus territorios.

18 N.º 686 · mayo de 2019 · Universidad de Antioquia
Altas cantidades de plásticos y contaminantes afectan la zona costera del urabá antioqueño. Foto: cortesía Daniel Steven Lamberto, estudiante de Ingeniería Oceanográfica.
Cumpliendo con el ejercicio de rendición de cuentas la Universidad de Antioquia presentó, el pasado 10 de abril, los avances de la gestión 2018. El rector John Jairo Arboleda resalta aquí los principales logros de ese periodo.
#INSTITUCIONAL
JOHN JAIRO ARBOLEDA CÉSPEDES
Rector de la Universidad de Antioquia rector@udea.edu.co
2018, un año de avances para la Universidad
El 2018 se caracterizó por la movilización social que consiguió poner en la agenda nacional el financiamiento de la educación superior pública. Se logró un acuerdo histórico porque desde la promulgación de la Ley 30 no se habían conseguido incrementos porcentuales por encima del IPC. A partir de los acuerdos pactados en diciembre se consiguió una inyección importante de recursos de base presupuestal, que se reflejarán entre 2019 y 2022.
En sintonía con esa reflexión, desde la Universidad de Antioquia nos propusimos una gestión racional y responsable de los recursos. Conseguimos incrementar los ingresos en 9000 millones de pesos, y una reducción de 6000 millones en gastos, sin afectar la prestación de los servicios. Al final del año, se alcanzó una disminución de 15 000 millones en el déficit que se había presupuestado para el 2018.
Ese año fue también el primero de nuestra gestión universitaria, cuyo primer paso fue conseguir la aprobación del Plan de Acción Institucional 2018-2021, inspirado en «Una Universidad de excelencia para el desarrollo integral, social y territorial».
Para presentar los avances de la gestión 2018 realizamos, el 10 de abril del 2019, la audiencia pública de rendición de cuentas, un espacio que concebimos como un ejercicio constante de interacción con los estamentos, los grupos de interés universitarios y la sociedad.
Como parte de ese compromiso y en esa búsqueda por mejorar las condiciones laborales de empleados y profesores, firmamos acuerdos con Sintraunicol y con Aspudea.
Emprendimos el proceso de autoevaluación con miras a la tercera acreditación institucional y empezamos la formulación participativa del Proyecto Educativo Institucional —PEI— que será la base de articulación de lineamientos pedagógicos, curriculares y didácticos.
También iniciamos la ejecución de dos proyectos en temas estratégicos para la región y el país, como el Centro de Desarrollo Agroindustrial en Innovación e Integración de Territorios —Cedait— y la alianza por la Sostenibilidad Energética para Colombia —Seneca—; financiados por el Sistema Nacional de Regalías y Colombia Científica, respectivamente.
Colciencias reconoció en la Universidad de Antioquia a la primera Oficina de Transferencia de Resultados de Investigación —OTRI— del país, un actor clave por su liderazgo en la misión de llevar resultados de investigación producidos en la academia, a las empresas y a la sociedad.
Creamos y pusimos en operación la Unidad Especial de Paz, una apuesta por contribuir, con un enfoque interdisciplinario, a la construcción de paz en los territorios. Y también creamos la Unidad de Resolución de Conflictos, para la prevención de violencias
y el manejo de situaciones de conflicto que afectan la convivencia universitaria. De igual forma, articulamos esfuerzos desde el interior de la Universidad y con entidades externas en la búsqueda de la formulación de una política institucional para la prevención y atención de las violencias sexuales y de género.
Pusimos en marcha la política de «cero papel» para la gestión digital de liquidación de matrícula de pregrado y expedición de diplomas y actas de grado. Así mismo, atendiendo nuestra responsabilidad con la transparencia, la disponibilidad y acceso a la información, iniciamos la implementación de DataUdeA, herramienta disponible en la web, que facilita la gestión y acceso a las principales cifras y datos relacionados con la gestión académica y administrativa.
Entre los retos del 2019, está seguir trabajando por la formalización laboral, para lo que realizaremos tres concursos públicos de méritos para empleados asistenciales, técnicos y profesionales, para ocupar las vacantes disponibles. Para profesores se hará un concurso público y además, estamos tramitando ante el Consejo Superior Universitario la creación de 60 plazas de profesores.
Continuaremos trabajando con responsabilidad y compromiso en la gestión transparente de los recursos, en esa relación constante con los universitarios y la sociedad, con dedicación y empeño en este compromiso que adquirimos hace más de un año.

19 N.º 686 · mayo de 2019 Universidad de Antioquia
Infografía: Mónica Valencia Arismendy.
Las matemáticas van más allá de usar fórmulas y resolver ejercicios. Con sus Olimpiadas de Matemáticas, la Universidad de Antioquia busca que los niños y jóvenes consoliden el aprendizaje de esta ciencia para el uso en su vida cotidiana.
#EDUCACIÓN
JENNIFER RESTREPO DE LA PAVA Periodista jennifer.restrepo@udea.edu.co
Olimpiadas para «cautivar» a jóvenes talentos matemáticos
¿Qué pasa por su mente cuando le hablan de matemáticas? A lo largo de los años las matemáticas se han posicionado en el imaginario de muchos como una ciencia poco útil para la vida cotidiana. El paradigma de su uso y utilidad en Colombia tiene además un componente cultural sobre la percepción del aprendizaje: son difíciles, aburridas y no hay mucho por descubrir.
Pese a su mala fama, las matemáticas no solo son una pasión sino también una vocación innata. Una buena muestra de ello son las Olimpiadas de Matemáticas que cada año realiza la Facultad de Ciencias Exactas y Naturales de la Universidad de Antioquia. En el 2018, por ejemplo, participaron en estas 8024 estudiantes provenientes de 195 instituciones educativas de primaria y básica secundaria, de 25 departamentos de Colombia, entre ellos Antioquia, Atlántico, Bolívar, Caldas, Cauca, Cesar, Córdoba, Cundinamarca, Huila, Meta, Norte de Santander, Quindío, San Andrés, Santander y Tolima.
Los resultados de las Olimpiadas evidencian las fortalezas y debilidades de los niños y jóvenes participantes. «La aritmética y el álgebra son las áreas más fuertes, se puede notar la calidad y horas de trabajo en los colegios dedicadas a estas áreas, pues los alumnos tienden a
ser rápidos en la resolución de estos problemas», destacó Breitner Ocampo, coordinador académico de las Olimpiadas.
Para él, la formación de esta ciencia se ha vuelto cíclica, tanto en la primaria, la secundaria y los estudios superiores. Muchos de los problemas no se alcanzan a resolver porque la persona no leyó bien, es decir, también hay falencias en comprensión lectora.
El mundo necesita matemáticos explosivos
Y es que la prevención generalizada por lo difíciles que pueden ser las matemáticas hace que ignoremos sus importantes aportes: están en casi todo lo que hacemos. Se emplean para predecir el clima, en las páginas web, en las transacciones bancarias, en la moda, la música y el arte, solo por mencionar algunas aplicaciones.
De otro lado, una parte de la matemática que se usa en los teléfonos celulares fue creada en los años 30, y también la teoría genética a partir de la matemática de Ivan Shestakov y Serguei demostraron cuáles son las alteraciones que se deben hacer al ADN humano para corregir enfermedades degenerativas como el cáncer y el alzhéimer.
Sin importar su área de estudio, el matemático debe estar en la capacidad de resolver con ingenio los problemas que se presenten. Allí radica la diferencia de la percepción y uso de esta ciencia en países como Francia y Alemania, donde los matemáticos hacen parte de la nómina en distintos campos de la industria, mientras que otros se dedican a la enseñanza.
Precisamente, las Olimpiadas de Matemáticas de la Alma Máter de los antioqueños tienen ese enfoque, pues más que medir conocimientos, buscan incentivar a que los niños y jóvenes extrapolen una información para resolver un problema.

20 N.º 686 · mayo de 2019 · Universidad de Antioquia
En el 2018 participaron niños y jóvenes de 25 departamentos de Colombia. En la foto un grupo de estudiantes de la Institución Educativa Acevedo y Gómez, sede Gabriel García Márquez, del municipio Puerto Rico, Caquetá. Foto: cortesía Olimpiadas de Matemáticas.
«La diferencia es la explosividad, la forma en que los estudiantes atacan el problema y lo resuelven sin pensar tanto en la teoría. Estamos buscando este tipo de talento, que tengan conciencia de lo que han aprendido y lo apliquen en diferentes situaciones», afirmó Ocampo. Para ello, según advierte, no es necesario un cambio curricular en la educación sino estímulos extra. Es fundamental motivar a los niños más que ponerlos a estudiar, pues un sobreesfuerzo puede abrumarlos.
«Así como se estimulan los deportes, los niños podrían tener un lugar donde les muestren experimentos, dibujos y alternativas para resolver problemas; algo más allá de lo que les enseñan en clase», enfatizó el matemático.
Los ejercicios de las Olimpiadas tienen cierto grado de complejidad basados en los estándares del Ministerio de Educación Nacional. «Si la prueba es de un alumno de sexto, recibe preguntas de quinto y séptimo para nivelar los conocimientos. Diseñamos problemas que se pueden solucionar sumando fracciones, pero jamás tendremos un ejercicio que pregunte directamente cuánto es el resultado de la suma de una fracción», agregó el coordinador académico del certamen.
En el 2018 la prueba incorporó la modalidad virtual para sus dos primeras fases. «Lo que nos permite la prueba virtual es analizar los exámenes a través de estadísticas. Al final cada colegio y cada alumno tienen un reporte separado por áreas, para que puedan conocer sus fortalezas y falencias», señaló John Harvey Vargas Cano, coordinador general de las Olimpiadas de Matemática.
Las Olimpiadas de Matemáticas se realizan desde 1996 y están adscritas al Instituto de Matemáticas de la Facultad de Ciencias Naturales y Exactas de la Universidad de Antioquia.
Estudiantes desde 4° hasta 11° de todo el país pueden participar en ellas.
Tienen tres fases de preguntas y cuatro categorías:
pensamiento numérico: aritmética, pensamiento espacial y métrico: geometría, pensamiento métrico y variacional: álgebra y cálculo,
pensamiento aleatorio: probabilidad y estadística.
Las inscripciones se realizarán hasta el 30 de mayo de 2019 en https://www.olimpiadasudea.co/matematicas/
#UDEAOPINIÓN
Todos somos auditorio
JUDITH NIETO
Profesora de la Escuela de Microbiología judith.nieto@udea.edu.co
En LaherenciadeEuropa , libro de ensayos del filósofo alemán Hans-Georg Gadamer, leí un capítulo titulado «Sobre los que enseñan y los que aprenden», en el que el mencionado pensador hace manifiesta su gratitud, en especial, a dos de sus maestros: Karl Jaspers y Martin Heidegger, de quienes Gadamer reconoce su capacidad para ejercer el magisterio, en particular por su exigencia al impartir sus lecciones, y por el llamado explícito a sus discípulos a mantenerse en actitud de aprendizaje —como debe ser—. Una actitud que hace posible reconocerse en falta frente al saber y, desde este lugar, asumir la urgencia de conocer por el que siempre estamos asistidos, pues en la ignorancia permanecemos, como lo enseña aquella sentencia socrática. Además de las lecciones recibidas de estos dos grandes pensadores que mantuvieron su espíritu de cara a la filosofía y al magisterio, Gadamer agradece de sus mentores la oportunidad que le concedieron para un día independizarse de sus lecciones, y hacer así posible que sus meditaciones tuvieran luz propia y se iniciara en su propia vocación de maestro. Una vocación cultivada por sus antecesores, pero ya a partir de su deseo y con el afán personal de poder comunicar un saber en cuya construcción y fomento los mismos tutores fueron figuras decisivas. Ese inquisitivo alumno se convirtió entonces en orientador definitivo en culturas y geografías lejanas, justamente gracias a que, en tanto hizo parte del auditorio frente al que estuvieron Jaspers y Heidegger, supo aprehender y conservar de ellos un legado invaluable: el don del extrañamiento.
La manifestación de agradecimiento a sus maestros hecha por el pensador de Marburg en las breves páginas que desde el título otorgan un lugar privilegiado a maestros y estudiantes, a los que enseñan y a los que aprenden, invita a su lectura y a las relecturas que sean posibles, pues la totalidad de su contenido conmueve de tal manera al lector que, además de sensibilizarlo a volver con sus ojos —y, esta vez, lápiz en mano— sobre las páginas ya leídas, lo lleva a constatar el efecto del decir, de la escucha y del legado del pensador y maestro que vio en sus discípulos el motivo para mantenerse en el ejercicio espiritual que es el magisterio.
Si en algo es magistral el texto que motiva estas líneas, es en el llamado de atención sobre el acto de escuchar. Saber escuchar, la disposición a la escucha, es la enorme invitación de Gadamer, quien también se dispuso a agradecer a sus formadores y a aprovechar dicho gesto para recordar que la educación, acto donde el decir se vigoriza, debe ser razón de encuentro y acontecimiento para propiciar la atenta escucha de la palabra portadora del pensamiento del otro, tanto la de quien ha optado por el «imposible» de educar, como la de quien asiste ávido, del otro lado del auditorio, en ese proceso. Lo expresado por Gadamer, adrede de la escucha en el ámbito educativo, merece destacarse en esta puntual reflexión a propósito de los maestros:
Así, en la conferencia que hoy ha pronunciado mi amigo Wlhelm Anz se me ha quedado grabada una conocida palabra que aún no había oído en este contexto. Por otra parte, solo la ha mencionado de paso. La palabra es: auditorio. Aquí no significa una reunión de estudiantes —como pertenece, sin duda, a mis ojos al aprendizaje del pensamiento—, sino que se refiere a todos nosotros. Todos somos auditorio, debemos aprender a escuchar, en uno u otro camino, a luchar siempre contra el ensimismamiento y eliminar el egoísmo y el afán de imposición de todo impulso intelectual. (Gadamer, 1990: 145-146) (Bastardillas de la autora).
Estas líneas, que sirven al autor para detenerse en la voz auditorio, confirman el valor de la escucha que subyace a la misión educativa, y que, en esencia, el estudiante obtiene reconocimiento y aprende a reconocer en tanto se sabe escuchado. «Todos somos auditorio» y, como integrantes de este, el llamado no es otro que el de disponer la escucha para la palabra destinada al maestro, integrante esencial del auditorio que es el salón de clases. Así, una educación que privilegia la escucha, que forma para este fin, augura la formación del juicio y, con esta, la esperanza del reconocimiento del otro, presente en los que enseñan y en los que aprenden.
«Sobre los que enseñan y los que aprenden» es una lectura oportuna para estos tiempos en los que la ignorancia, abono del ensimismamiento, da por verdaderas las más grandes mentiras, mientras las verdades son socavadas por el peso de la sospecha que recae en quien las defiende.
Gadamer, H. G. (1990). «Sobre los que enseñan y los que aprenden». En La herencia de Europa (145-146). Barcelona: Península.
21 N.º 686 · mayo de 2019 Universidad de Antioquia
Aunque se empiezan a materializar algunas de las conquistas financieras del movimiento social por la educación superior del 2018, persiste la urgencia de incluir en la discusión del Plan Nacional de Desarrollo, la modificación a la Ley 30 de 1992 y sus artículos 86 y 87.
#ANÁLISIS
RAMÓN JAVIER MESA CALLEJAS
Profesor Facultad de Ciencias Económicas ramon.mesa@udea.edu.co
Sostenibilidad de las IES, base para modificar la Ley 30
Los acuerdos alcanzados en diciembre de 2018 por la histórica lucha de estudiantes y profesores representan un paso importante para resolver los problemas estructurales de las instituciones de educación superior —IES—.
Los nuevos recursos pactados buscan poner freno al desequilibrio financiero generado por la Ley 30 de 1992, que desde su creación indexó las transferencias de la Nación a las universidades al ritmo del índice de precios al consumidor —IPC— y no contempló los aumentos reales de los costos de la educación, que siempre han estado más de cuatro puntos por encima del IPC, como lo ha advertido la Comisión técnica de vicerrectores administrativos y financieros del Sistema Universitario Estatal —SUE—.
Con esta idea, se incluyó el artículo 108 en el Plan Nacional de Desarrollo —PND— 2018-2022. Allí quedaron consignadas las partidas adicionales al IPC para atender los gastos de funcionamiento de las IES para el período del presidente Duque, que como bien se conoce corresponde a: 3.5 % en 2019, 4 % en 2020, 4.5 % en 2021 y 4.65 % en 2022.
Como política de Gobierno es un avance, sin embargo, como política de Estado a favor de la educación superior pública, el PND no presenta modificaciones a la Ley 30 en los artículos 86 y 87, las cuales son determinantes.
¿Por qué se necesita modificar la Ley 30?
Las modificaciones de fondo a la Ley 30 permitirían igualar las transferencias que reciben del Estado las IES por la vía del presupuesto general de la Nación y de las entidades territoriales, a los costos en que hoy incurren dichas instituciones.
Lo anterior tiene justificaciones. El carácter social y público de la educación exige financiación adecuada, que le permita a las IES atender asuntos misionales importantes, diferentes a sus gastos de funcionamiento. Ante este panorama, el esfuerzo de las instituciones para cubrir los costos crecientes que representa cubrir lo misional ha sido significativo; de acuerdo con la comisión técnica del SUE, la generación de recursos propios constituye, en promedio, cerca del 50 % del presupuesto de muchas instituciones.
También, una parte importante de los gastos se concentra en la nómina. Según la Comisión, anualmente los gastos de personal representan 108 000 millones de pesos a la base presupuestal para las universidades oficiales, constituidos por aumentos salariales del 1 % adicional al IPC aprobado por el Gobierno nacional, y por los incrementos en las nóminas docentes por el efecto del Decreto 1279 de 2002, que establece como mínimo el 3 % adicional al IPC. Si bien, para 2019 los recursos adicionales logrados en el acuerdo para funcionamiento ascienden a 103 954 millones de
pesos para repartir entre 32 universidades, en los últimos 5 años estos gastos habían superado los 536 000 millones.
Reformar los artículos 86 y 87
Desde la comisión técnica se ha propuesto que sostener este aparataje anual debe ser el ideal para ajustar el artículo 86 a la realidad financiera de las instituciones, lo cual implicaría un incremento adicional permanente a la base presupuestal de las IES por encima del IPC a partir del año 2023, que supere como mínimo lo acordado para el 2022 de 4.65 %.
Esto garantizaría su funcionamiento y sostenibilidad, al incluir los incrementos de los gastos de personal en sus presupuestos. Si se modifica el artículo 87, también se podría potencializar la inversión social que hacen las instituciones en distintos rubros. La propuesta es que sea el 10 % de la base presupuestal que se entrega al SUE.
En efecto, el ajuste consiste en destinar este porcentaje para atender la inversión social que hacen las instituciones para mayor cobertura, mejorar infraestructura, bienestar, formación de los profesores, internacionalización de estudiantes y docentes, bilingüismo, entre otros temas. Dichos aportes, para 2019, están calculados en cerca de 300 000 millones de pesos. Estos recursos permitirán disminuir gradualmente las brechas de calidad que se calculan en cerca de 13.7 billones de pesos como resultado del desequilibrio financiero de la Ley 30.
Para la vigencia 2019, por artículo 87, el MEN distribuirá 29 447 millones, estos recursos se calculan a partir de un porcentaje no inferior al 30 % de incremento real del crecimiento del Producto Interno Bruto —PIB— de 2018.
En general, estas modificaciones exigen de un esfuerzo fiscal importante por parte del Estado, pero también, de fortalecer las fuentes de recursos propios de las IES con la idea de apalancar, con criterios de eficiencia y equidad, los gastos corrientes y la inversión social de las instituciones. De la misma manera, es importante hacer explícito y directo que las ciudades capitales hagan base presupuestal de todas las IES que tienen presencia en sus territorios. En el caso del Municipio de Medellín, no se entiende que este no haga base presupuestal de la Universidad de Antioquia, cuando se beneficia de uno de los valores agregados que genera la institución, representado en la matrícula de pregrado de más del 50 % del total de estudiantes que son residentes de Medellín.
En suma, garantizar la sostenibilidad financiera de la educación superior pública es un deber y una obligación que tiene el Estado colombiano, para contribuir al desarrollo y mejoramiento de la calidad de vida de la sociedad colombiana más vulnerable.
22 N.º 686 · mayo de 2019 · Universidad de Antioquia
ELVIA
MARÍA GONZÁLEZ AGUDELO
Profesora
de
la
Facultad de Educación elvia.gonzalez@udea.edu.co
¿Somos
maestros?
#UDEAOPINIÓN
Nos han enseñado, desde la educación media, que existieron hace muchos siglos tres grandes filósofos en Grecia: Sócrates, Platón y Aristóteles, cada uno maestro de quien le sucedió; ahora bien, también nos enseñaron que cada uno de ellos creó su propio método para sus elaboraciones filosóficas: la mayéutica de Sócrates, la dialéctica de Platón y los silogismos de Aristóteles; además, utilizaban estos métodos para enseñar en su propio espacio: el «gimnasio» de Sócrates, la «academia» de Platón y el «liceo» de Aristóteles. Los tres métodos tenían en común el diálogo.
En Sócrates, la mayéutica es el arte de conversar, preguntas que conducen a respuestas determinadas. Para iniciar el diálogo pregunta con exclamaciones motivadoras sobre la vida misma; ante las respuestas, el maestro objetaba irónicamente, en forma de preguntas, y demuestra la falsedad de lo dicho, la ignorancia del otro, antes reconocida en él, de ahí su famoso «solo sé que nada sé», hasta lograr que ese otro llegue a una verdad, a manera de definición general, universalmente reconocida; llegó a ello porque Sócrates lo asistió, él se consideraba a sí mismo como un partero. Al gimnasio asistía Platón, aprendió la mayéutica de Sócrates, su maestro, y lo inmortalizó escribiendo sus diálogos, pero en el camino, lo dejó atrás y elaboró su propio método: la dialéctica.
En Platón, la dialéctica es también el arte de conversar, pero con preguntas y respuestas que provocan discusión para examinar ideas, explorar contradicciones, autocriticarse, elaborar conceptos y llegar al principio de todo, y desde allí, deducir, concluir y demostrar la verdad; es el arte de pensar ligado al lenguaje, es un proceder de carácter abstracto, formal, ideal, de relaciones entre signos, entre contenidos simbólicos. A la academia asistió Aristóteles, y al igual que Platón, aprendió la dialéctica de su maestro, pero en el camino, lo dejó atrás y elaboró su propio método: los silogismos.
En Aristóteles, los silogismos son proposiciones que utilizan el lenguaje correctamente, a partir de observaciones que llevan los casos singulares a una noción universal. Proposiciones, falsas o verdaderas, conformadas por conceptos que se vinculan y conllevan a una conclusión necesaria; aunque es un proceder demostrativo, se basa en lo empírico y no solo en las ideas, como lo planteaba Platón. Así, se va configurando el método inductivo donde, luego de muchos siglos, avanzaron Bacon y Descartes. Así mismo, a la dialéctica llegaron Hegel y Marx, con la tesis, la antítesis y la síntesis, y la elaboración de sus propias teorías; desde allí se abre el abanico a la hermenéutica: Schleiermacher, Boeckh, Droysen, Dilthey, Husserl, Heidegger, Gadamer, Habermas, otro hilo de maestros y alumnos que fueron entretejiendo métodos para las ciencias, para la enseñanza, produciendo contenidos, escribiendo libros y generando nuevos espacios, como las escuelas catedralicias para la sabiduría, los colegios, las universidades para la profesionalización, para la investigación y para la extensión. Además, desde el siglo XVI llega la enseñanza masiva como una de las innovaciones sociales más trascendentales de la humanidad, con su antecesor, la imprenta y su producción masiva. Pero ahora, con la cuarta revolución industrial, los productos de las ciencias están en la nube, en acceso abierto para todos, entonces ¿cuál es la diferencia entre maestro y alumno?, ¿qué clase de maestros somos?, ¿conversamos con nuestros estudiantes?, ¿qué le hemos aportado a la metodología de nuestras investigaciones?, ¿qué le hemos aportado a la didáctica universitaria?, ¿enseñamos como investigamos?, ¿quiénes fueron nuestros maestros?, ¿cómo hemos trascendido a nuestros maestros? Y por demás, ¿dónde andan nuestros estudiantes?, ¿qué le estarán aportando a la humanidad?
CARLO EMILIO PIAZZINI SUÁREZ
Profesor del Instituto de Estudios Regionales carlo.piazzini@udea.edu.co
Galeón San José: urge una decisión de fondo
Desde que inició su mandato, Juan Manuel Santos —hoy expresidente— puso en marcha una estrategia política y legislativa para permitir la explotación y comercialización, por parte de empresarios extranjeros, de los vestigios del galeón San José, un buque naufragado en 1708 en cercanía a las Islas del Rosario, del que se presume transportaba una carga compuesta por metales y piedras preciosas, entre otros contenidos.
Primero, contra las advertencias efectuadas por varios sectores académicos nacionales e internacionales, expidió una ley —la 1675 de 2013— que retiró el carácter de patrimonio arqueológico, y por lo tanto el régimen constitucional de inalienabilidad, a aquellos objetos del naufragio con mayor valor en el mercado internacional de antigüedades —lingotes, monedas y otros objetos de oro y plata, perlas y esmeraldas—. Después, contrató secretamente con la empresa caza tesoros Maritime Archaeology Consultants —MAC— una exploración submarina que dio como resultado el hallazgo, en 2015, de evidencias que muy probablemente correspondan con ese naufragio.
Luego, el Gobierno Santos diseñó, con apoyo de la misma empresa, un proceso de licitación para el rescate de los bienes del galeón, operación cuyos altos costos de ejecución y ganancias esperadas deben pagarse con el valor de los hallazgos mismos. Debido a demandas que denuncian irregularidades en el proceso, la licitación ha tenido que ser suspendida varias veces.
El Gobierno del presidente Iván Duque heredó una situación compleja. Ahora debe responder, prontamente y sin dilaciones, al cuestionamiento de si los vestigios del galeón son un botín; o si, por el contrario, son las huellas tangibles de otros tiempos, testimonio necesario para reconstruir procesos históricos y nuevas memorias. Es decir, ¿son tesoro o son patrimonio arqueológico?
Si decide reactivar la licitación, propiciará un magnífico negocio para el único proponente, la empresa MAC, mientras que al país le quedarán un laboratorio y un museo en Cartagena, y algunos recursos financieros para el Ministerio de Cultura y el Instituto Colombiano de Antropología e Historia, —ICANH—, todo ello a costa de la venta del patrimonio cultural sumergido de la Nación y de la integridad del yacimiento arqueológico del galeón. Haría realidad el negocio soñado de Santos, erosionando una disposición constitucional que ha valorado y protegido el patrimonio arqueológico como bien público.
Esa decisión permitiría que prosperen otras iniciativas de explotación comercial del patrimonio arqueológico marítimo y terrestre. Adicionalmente, se afectarán las relaciones con la Unesco, que ha manifestado su desacuerdo con la legislación y la licitación porque conducen a la comercialización de bienes que, de acuerdo con la Convención de Patrimonio Cultural Sumergido de 2001, deben ser inalienables. Así mismo, se afectarían las relaciones con el Estado español, que ha criticado el proceso de licitación porque considera que el buque, al ser de bandera española, hace parte de su patrimonio cultural.
Si, por el contrario, suspende definitivamente la licitación, además de evitar el deterioro del yacimiento, y proteger los bienes que lo integran, generará condiciones fundamentales para la formulación de una política pública sobre patrimonio cultural sumergido y la aplicación de un programa de investigaciones de largo plazo, que permita intervenir apropiadamente el naufragio, generar conocimiento sobre su valor histórico, científico y cultural, y fortalecer las capacidades locales en la materia. Esta iniciativa ha sido expuesta en detalle al actual Gobierno y a la opinión pública, por la Red Universitaria de Patrimonio Arqueológico Sumergido, una iniciativa nacional puesta en marcha por la Universidad de Antioquia desde julio de 2018. No cabe aquí una solución intermedia del tipo: vendamos una parte del galeón como tesoro y conservemos la otra como patrimonio. Tampoco aquella —que lamentablemente parece estar explorándose—, de llegar a un acuerdo con MAC para extraer los bienes sin comercializarlos. Señor presidente: quedar bien con todas las partes es en este caso imposible. El país necesita una decisión de fondo.
23 N.º 686 · mayo de 2019 Universidad de Antioquia
La instalación Espacio dócil, del artista plástico Germán Sánchez Restrepo, propone ocho piezas sobre la interacción entre movimiento-luz-sonido. El espectador es el encargado de activar todas las reflexiones.
#ARTE
Tránsitos del sonido y la luz
Uno de los compositores vanguardistas que más se preocupó por el fenómeno del sonido fue John Cage. A través de músicas y ruidos, dejó algunas reflexiones: «Ni estando en un cuarto aislado ni quedándonos estáticos podemos lograr que haya un silencio total; el latido del corazón, el sonido de nuestra respiración o el simple andar del viento lo impiden», anotó en 1952, después de haber visitado la cámara anecoica —herméticamente sellada— de la Universidad de Harvard. La visita de Cage al lugar estuvo motivada por sus estudios sobre el silencio en una época en la que abundaban las propuestas musicales. De allí nació 4’33”, una obra que evidencia que el silencio es cercano a la utopía. Estas referencias llegaron a los oídos del artista plástico Germán Sánchez Restrepo y se cruzaron con sus indagaciones sobre los espacios privado y público. Fue el génesis de Espacio dócil: un estudio sobre la sonoridad de la quietud, obra que se expone hasta el 30 de mayo en el Museo Universitario de la Universidad de Antioquia —Muua—, que propone la sinestesia como puente sensorial a los espectadores —oler un sonido, observar un olor, palpar un color, oír un sabor—.
Los sonidos que se activan en la sala están construidos a partir de ruidos, uno de ellos el televisivo, con el cual el artista
NATALIA PIEDRAHITA TAMAYO Periodista natalia.piedrahita@udea.edu.co
propone una reflexión sobre los paradigmas que moldean el espacio: «La televisión genera espectadores pasivos, que asimilan la luz, el sonido y el movimiento sin cuestionar mucho; asimismo el espacio público se ha convertido en un fantasma que todos deben soportar, está ahí a pesar de que nos guste o no», explicó Sánchez.
El individuo establece valores luminosos y acústicos sobre su experiencia de lo deseable y lo no deseable, que Sánchez Restrepo denomina lugares y no lugares. «En los no lugares todos somos desconocidos y sospechosos». Los no lugares son, entonces, los espacios urbanos, donde todo es de todos pero de nadie, ellos causan la búsqueda del sujeto por un espacio «más íntimo y seguro», un comportamiento «claustrofílico».
La instalación —cuadros blancos, sensores, luces ledes y sonido— es uno de los trabajos de investigación financiado por el Fondo de apoyo a trabajos de grado de la Facultad de Artes de la Universidad de Antioquia; y está compuesta por ocho piezas experimentales que invitan a caminar, danzar, observar, activar, según la sensibilidad del espectador.
«Todo cambia todo el tiempo, por ello, aunque la obra nazca de una reflexión, no tiene una pretensión diferente a la que despierte en el espectador», dijo el artista Sánchez Restrepo.

24 N.º 686 · mayo de 2019 · Universidad de Antioquia
Instalación Espacio dócil Museo Universitario de la Universidad de Antioquia: Foto: Juan Pablo Hernández Sánchez.